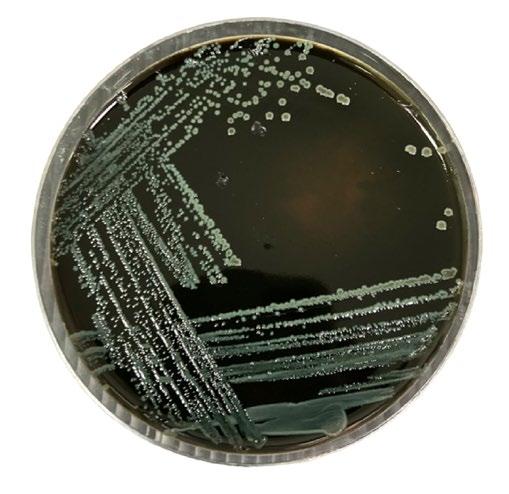
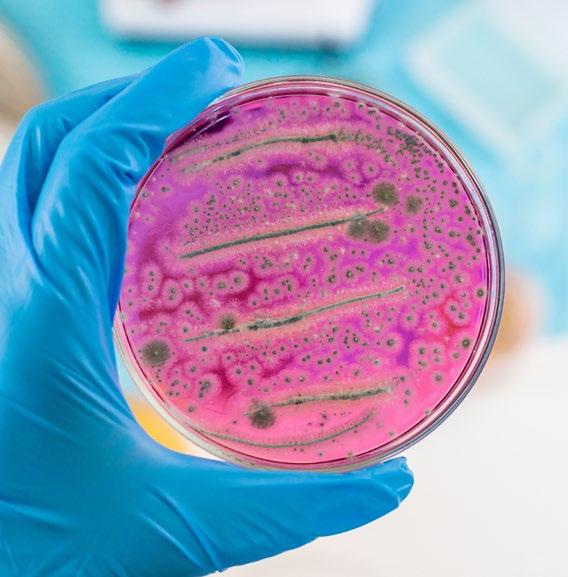

EDITORIALE
























Anno IX - N. 2 Febbraio 2026
Edizione mensile di Bio’s
Testata registrata al n. 113/2021 del Tribunale di Roma
Diffusione: www.fnob.it
Direttore responsabile: Vincenzo D’Anna
Questo magazine digitale è scaricabile on-line dal sito internet www.fnob.it
Questo numero del “Giornale dei Biologi” è stato chiuso in redazione il 26 febbraio 2026.
Gli articoli e le note firmate esprimono solo l’opinione dell’autore e non impegnano la Federazione Nazionale degli Ordini dei Biologi.
Immagine di copertina: @ Shutterstock AI/shutterstock.com
Si informano gli iscritti che gli uffici della Federazione forniranno informazioni telefoniche di carattere generale dal lunedì al giovedì dalle 9:00 alle ore 13:30 e dalle ore 15:00 alle ore 17:00. Il venerdì dalle ore 9:00 alle ore 13:00
Tutte le comunicazioni dovranno pervenire tramite posta (presso Federazione Nazionale degli Ordini dei Biologi, via Icilio 7, 00153 Roma) o all’indirizzo protocollo@cert.fnob.it, indicando nell’oggetto l’ufficio a cui la comunicazione è destinata.
È possibile recarsi presso le sedi della Federazione Nazionale degli Ordini dei Biologi previo appuntamento e soltanto qualora non sia possibile ricevere assistenza telematica. L’appuntamento va concordato con l’ufficio interessato tramite mail o telefono.
Centralino 06 57090 200
Ufficio protocollo protocollo@cert.fnob.it
di Vincenzo D’Anna
Presidente della Federazione Nazionale degli Ordini dei Biologi
Se non avessimo a soffrire dell’incomunicabilità, dell’indifferenza che una parte degli iscritti
all’Albo dei Biologi manifesta per le molteplici attività che la Federazione Nazionale degli Ordini, la Fondazione italiana e gli Ordini territoriali più attivi propongono agli iscritti, l’articolato progetto delle Scuole di Formazione permanenti sul campo sarebbe già noto a tutti.
E tuttavia così non è ancora, ancorché il numero degli accessi al sito istituzionale della FNOB (che fa registrare
mediamente oltre 350mila visualizzazioni al mese) sia sensibilmente aumentato e che, al contempo, l’ottanta per cento degli iscritti acceda all’Area Riservata dello stesso portale.
Farà piacere sapere - a coloro che già ne conoscono tipologia di attività e modalità di funzionamento, e spero anche a quanti solo adesso
Le Scuole di Formazione sono una realtà già funzionante per quella di Genetica e Genomica con sede in Roma

L’ammissione avverrà per avviso pubblico e le domande saranno vagliate da una Commissione di esperti del settore e dal direttore della Scuola
ne hanno avuto conoscenza - che tali Scuole sono, penso, una realtà già funzionante per quella di Genetica e Genomica con sede in Roma, e siano in procinto di partire per tutte le altre cinque. Queste ultime verranno inaugurate nel corso dell’anno e, repetita iuvant, riguardano: l’Embriologia Clinica e PMA (Roma); la Biologia Marina (Reggio Calabria); la Bioinformatica (Firenze); la Nutrizione Sportiva e quella Generale (Milano); il Biorestauro dei monumenti e delle opere d’arte (Pompei). Altre ne sa -
ranno aperte in Tossicologia Ambientale, Ecotossicologia e Sicurezza Alimentare.
Le domande che giungono più frequentemente da parte dei colleghi che si mostrano interessati sono prevalentemente due: come avviene l’ammissione alle scuole e se parteciparvi ha un costo. Ebbene, l’ammissione avverrà per avviso pubblico e le domande saranno vagliate da una Commissione di esperti del settore e dal direttore della Scuola, già individuato per competenza nel ramo. Gli oneri economici, minimi e volti alla copertura delle spese vive, saranno di gran lunga accessibili a tutti e molto più bassi di quelli che normalmente costa l’iscrizione ad un Master. Borse di studio, inoltre, ver -
ranno assegnate ai colleghi che saranno in possesso dei requisiti opportunamente individuati, per merito e per reddito, oltre che per la priorità che sarà valutata per i colleghi che avranno raggiunto il livello minimo di rating. Quest’ultimo, lo rammentiamo, è calcolato sulla base delle frequenze di accesso ai canali di informazione della Federazione e della partecipazione agli eventi scientifici patrocinati oppure organizzati dalla medesima.
La terza domanda, credo la più dirimente, è quella che chiede quale scopo e quale utilità abbiano le iniziative fin qui illustrate. La risposta è semplice: permettere ai colleghi inesperti in un determinato campo di esercizio della professione, ossia
quelli indicati, l’acquisizione di una capacità operativa, di una minima pratica professionalizzante acquisita sul campo dell’applicazione.
L’introduzione a breve dei
Decreti Interministeriali, contenenti la nuova normativa riguardante l’aggiornamento e l’implementazione delle competenze professionali assegnate ai Biologi, varrà come ulteriore stimolo a fare pratica di "esercizio" nelle nuove acquisizioni di competenze professionali. Non è esagerato affermare che stiamo transitando, come categoria, nel Terzo
L’introduzione a breve dei Decreti Interministeriali varrà come ulteriore stimolo a fare pratica di "esercizio" nelle nuove competenze
Nessuno sarà lasciato in balia dell’indeterminatezza sulle scelte che potrà fare. In fondo il nostro compito è quello di guidare i colleghi
Millennio di una professione che si espande continuamente e che, assecondata con la teoria e la pratica, dischiuderà a centinaia di nuovi iscritti prospettive di inserimento lavorativo impensabili e insperate. Ma non è che l’inizio e ci attrezziamo a dare tutele giuridiche e nuovi saperi a coloro che dovranno attraversare questo secolo.
E per indicare le nuove strade - dopo aver ampliato e ammodernato quelle già battute nel secolo scorsopresenteremo l'Albero delle opportunità con l’ausilio
dell’intelligenza artificiale. I giovani e coloro che, meno giovani, intendono cambiare ambito di esercizio professionale potranno consultare tale "modello" con l’ausilio di un Avatar che indicherà a ciascuno una delle ottanta diverse possibilità di inserimento nel mondo del lavoro. All'inizio di ogni sentiero gli interpellanti troveranno un filmato prodotto da un autorevole collega che indica e spiega le opportunità, le difficoltà, gli inserimenti nel mondo delle professioni. Nessuno sarà lasciato in balia dell’indeterminatezza sulle scelte che potrà fare. In fondo il nostro compito è quello di guidare e di accompagnare i colleghi a vincere la battaglia con l'esistenza, sotto la tazza capovolta del cielo.


Procedure di laboratorio, gestione di gameti ed embrioni, tecniche di fecondazione: presto l'attivazione di una scuola permanente dedicata al settore da parte della Fib
©YAKOBCHUKVIACHESLAV/shutterstock.com

LA FONDAZIONE ITALIANA BIOLOGI SI OCCUPA DI PROMUOVERE LA RICERCA
SCIENTIFICA, LA FORMAZIONE
PROFESSIONALE E DI VALORIZZARE
L'IMMAGINE DELLA CATEGORIA, AFFINCHÉ I BIOLOGI POSSANO
RICEVERE UN'ACCURATA
PREPARAZIONE SCIENTIFICA E PRATICA
Una Scuola permamente dedicata all'Embriologia clinica, disciplina in cui il ruolo dei biologi è attivo, preminente ed essenziale. La attiverà presto la Fib, la Fondazione Italiana Biologi, costola operativa della FNOB che si occupa di promuovere la ricerca scientifica, la formazione professionale e di valorizzare l'immagine della categoria, affinché i biologi possano ricevere un'accurata preparazione scientifica e pratica in questo settore cruciale.
Il progetto preliminare è nero su bianco, con le sedi per i tirocini che coinvolgono strutture pubbliche e private e il gruppo di coordinamento scientifico e organizzativo già all'opera con la definizione dei moduli per le 100 ore di docenza frontale e le 150 di frequentazione nelle sedi coinvolte per i tirocini pratici. Un corso senza oneri a carico della Federazione Nazionale degli Ordini dei Biologi e la cui partecipazione avverrà a titolo gratuito, senza corresponsione di quote di iscrizione da parte dei partecipanti.
Alla figura del biologo della riproduzione fanno capo le responsabilità delle procedure di laboratorio nella PMA, la procreazione medicalmente assisita, la gestione di gameti ed embrioni, l'esecuzione delle diverse tecniche di fecondazione. Si tratta di un ruolo centrale, determinante. Il biologo, in base alla sua preparazione ed esperienza, sceglie gli strumenti, i terreni di coltura e i materiali più adatti per i gameti e gli embrioni, seleziona gli spermatozoi, prepara gli embrioni per il trasferimento all'interno dell'utero, ma anche i trattamenti specifici per il trattamento dei gameti maschili e femminili allo scopo di
IL BIOLOGO SPECIALISTA IN EMBRIOLOGIA CLINICA È IL
PROFESSIONISTA DI RIFERIMENTO PER LE COPPIE CHE
HANNO DIFFICOLTÀ NEL CONCEPIMENTO O CHE SONO ALLE
PRESE CON DIAGNOSI DI INFERTILITÀ, CON PROBLEMATICHE
GENETICHE CHE IMPEDISCONO LA PROSECUZIONE DI UNA
GRAVIDANZA AVVIATA, POLIABORTIVITÀ E CON ALTRI TIPI DI
OSTACOLI ALLE LORO LEGITTIME ASPIRAZIONI

ottenere la fecondazione in vitro e la successiva formazione e trasferimento dell'embrione in utero. Non solo. Col perfezionarsi delle procedure di ricerca genetica, l'embriologo clinico (che è sinonimo di biologo della riproduzione) riveste un ruolo cruciale anche nell'individuazione dei disordini genetici alla base di malattie trasmissibili note o delle aneuploidie (alterazioni del numero dei cromosomi) di embrioni e gameti.
Il biologo specialista in Embriologia clinica, dunque, è il professionista di riferimento per le coppie che hanno difficoltà nel concepimento o che sono alle prese con diagnosi di infertilità, con problematiche genetiche che impediscono la prosecuzione di una gravidanza avviata, poliabortività e con altri tipi di ostacoli alle loro legittime aspirazioni.
L'OMS considera l'infertilità una patologia e suggerisce accertamenti se non si arriva al concepimento dopo 12 mesi di rapporti regolari e non protetti, che scendono a sei in caso la donna abbia un'età superiore a 35 anni o in presenza di fattori di rischio quali precedenti interventi chirurgici, infezioni uterine o particolari patologie. Anche in questo ambito, naturalmente, più tempestiva è la diagnosi, più alta è la percentuale di successo degli interventi.
Ma come funziona la PMA e quali sono le tecniche e i trattamenti messi in campo per favorire o garantire lo sviluppo di una gravidanza? Le tecniche di procreazione medicalmente assistita si distinguono in tre livelli. Del primo fa parte l'inseminazione intrauterina, dove il liquido seminale viene preparato in laboratorio e depositato all'interno dell'utero al fine di aumentare la densità dei gameti, facilitando l'incontro tra spermatozoi e ovocita. La percentuale di successo è del 10-20% per ogni ciclo. Al secondo appartengono le tecniche di inseminazione in vitro, basate sul prelievo chirurgico degli spermatozoi e la crioconservazione di
gameti maschili, femminili ed embrioni.
Nella FIVET gli ovociti e gli spermatozoi vengono messi a contatto su piastre, favorendo la fecondazione del gamete femminile attraverso l'ingresso spontaneo dello spermatozoo. Le probabilità di successo vanno dal 30-45% per le donne più giovani al 10% per le donne over 43, ma salgono al 90% dopo tre cicli di trattamento. Nella ICSI, che si adotta nei casi di infertilità maschile più severi o in caso di insuccesso della tecnica FIVET, lo spermatozoo è iniettato direttamente all'interno dell'ovocita. La percentuale di succeso della fecondazione è del 30-50%, che sale al 75% dopo tre cicli.
Mentre le tecniche di secondo livello sono eseguibili in anestesia locale, quelle di terzo livello necessitano di anestesia generale con intubazione e prevedono il prelievo microchirurgico di gameti dal testicolo, il prelievo degli ovociti per via laparoscopica e il trasferimento intratubarico dei gameti maschili
e femminili (GIFT) per via laparoscopica, con percentuali di successo del 30-50% che però scendono drasticamente dopo i 40 anni.
Dal 2014 in Italia è consentita la fecondazione eterologa, che prevede il ricorso a ovulo o seme di donatori esterni alla coppia: nel caso di ovulo e seme interni alla coppia si parla di fecondazione omologa.
Alla fecondazione eterologa, riservata a coppie eterosessuali maggiorenni, conviventi o sposate, si può ricorrere in presenza di sterilità assoluta femminile (menopausa precoce) o maschile (assenza di spermatozoi) certificate, ma anche dopo ripetuti fallimenti di tecniche di fecondazione omologa o in caso di rischio che il nascituro possa sviluppare malattie genetiche. Il limite di età per la donna per questo tipo di trattamenti è 46 anni. Sempre dal 2014 è consentito l'utilizzo di embrioni e ovociti crioconservati attraverso tecniche quali FER e FO, precedentemente vietate dalla legge 40/2004.


Quando una donna non riesce a sviluppare una gravidanza si è portati a pensare che possa avere pro blemi di fertilità.
Più difficilmente, o solo in un secondo momento, l'attenzione si sposta sul partner. In realtà l'infertilità è questione che coinvolge tanto le donne quanto gli uomini. Soprattutto nei paesi industrializzati come l'Italia si fanno figli sempre più tardi.
Questo può influire sulla fecondazione e sulla buona riuscita di una gravidanza. Abbiamo visto, infatti, quanto l'età dell'aspirante madre sia rilevante nella buona riuscita dei trattamenti di Embriologia clinica e PMA.
Per l'uomo non è tanto l'anagrafe a contare, quanto la qualità spermatica. Soprattutto negli ultimi anni, sono sempre di più i giovani che mostrano segni di infertilità o comunque di ridotta capacità riproduttiva. Si stima che l'infertilità interessi il 7% della popolazione maschile, intendendo per infertilità una produzione insufficiente di spermatozoi o anomalie nella qualità degli spermatozoi prodotti.
Nei casi di sterilità, invece, c'è assenza totale di spermatozoi nel liquido seminale (azoospermia) oppure nel liquido seminale sono presenti spermatozoi morti (necrozoospermia).
Anche fattori ambientali sono coinvolti nella riduzione della conta degli
Negli ultimi anni la qualità spermatica è in peggioramento, in Italia e nel mondo, ed è più difficile procreare
spermatozoi. Stili di vita irregolari, inquinamento, sedentarietà, fumo e diete poco sane sembrano influenzare direttamente l'astenozoospermia, la condizione di cui soffrono uomini con un ridotto contenuto di spermatozoi mobili. Le cause dell'infertilità maschile possono dipendere da ragioni pre-testicolari (malattie endocrine, dell'ipotalamo o dell'ipofisi), testicolari (alterazioni nella produzione degli spermatozoi) o post-testicolari (alterazioni e disfunzioni sessuali).
Le condizioni che portano all'infertilità nell'uomo non hanno sintomi evidenti. Fa eccezione il varicocele, una dilatazione delle vene spermatiche interne che determina una concentrazione di sostanze tossiche, che spesso provoca una sensazione di fastidio o di peso a livello dello scroto. Le infiammazioni dei canali uroseminali sono invece accompagnate da bruciori e fastidi. Per la valutazione della fertilità maschile l'esame principale è costituito dallo spermiogramma, che consente di valutare volume, concentrazione, morfologia e viscosità dello sperma.
Il test di capacitazione valuta invece la capacità degli spermatozoi di sopravvivere a contatto con l'apparato riproduttivo femminile. Negli ultimi tempi sono sempre più prescritti esami genetici: analisi dei cromosomi, ricerca di microdelezioni del cromosoma Y, analisi di mutazioni geniche per la fibrosi cistica, che rappresentano le alterazioni genetiche più comuni associate a infertilità maschile. L'epigenetica, lo studio delle modificazioni strutturali del genoma che non alterano la sequenza del DNA, è cruciale nello studio dei problemi di infertilità maschile. Uno dei principali meccanismi epigenetici, la metilazione del DNA, è infatti un processo chiamato in causa nella spermatogenesi e in grado di influenzare direttamente la fertilità. (R. D.).
Riconosciuta come trattamento essenziale per la salute riproduttiva, ma restano ritardi e disuguaglianze
Da quando è stata autorizzata dalla legge 40/2004, la Procreazione Medicalmene Assisita ha consentito la nascita di più di 200mila bambini in Italia. Il Registro Nazionale della PMA, istituito presso l'Istituto Superiore di Sanità, ha certificato nel 2024 in 217mila le gravidanze a termine in venti anni, con una percentuale di succeso dei trattamenti via via più alta.
Numeri che testimoniano l'importanza della PMA e dei trattamenti a essa correlati e che potrebbero migliorare ancora nel prossimo futuro, visto che dal 2025 la PMA è stata inserita nei LEA, i livelli essenziali di assistenza del Servizio Sanitario Nazionale. Una svolta che dovrebbe garantire un accesso più equo e più generalizzato ai trattamenti, riducendo disparità territoriali ed economiche e offrendo delle possibilità in più a un numero maggiore di coppie. La PMA è stata riconosciuta come un trattamento essenziale per la salute riproduttiva.
La fecondazione assistita, sia omologa sia eterologa, deve essere erogata come prestazione ambulatoriale e non in regime di ricovero, con sei tentativi di PMA coperti dal SSN per le donne fino ai 46 anni, senza esclusione di tecniche, a costi uniformi per tutte le regioni. Tra i trattamenti garantiti quelli di inseminazione intrauterina (IUI), la fecondazione in vitro (FIVET) e l'iniezione intracitoplasmatica dello spermatozoo (ICSI). Restano esclusi dai LEA, invece, la diagnosi genetica preimpianto (PGT), la conservazione degli ovociti per motivi non strettamente medici oltre a specifici percorsi personalizzati con l'ausilio di tecnologie più avanzate, che rimangono disponibili presso strutture private.
L'inserimento della PMA nei LEA

non garantisce, purtroppo, uniformità su tutto il territorio nazionale: le prime applicazioni della nuova normativa evidenziano già differenze piuttosto significative tra le diverse regioni, soprattutto per quanto riguarda i tempi di attesa e di erogazione dei rimborsi. Una questione che non riguarda soltanto questo settore specifico, ma un po' tutte le prestazioni inserite nei LEA. Ecco perché in tanti continuano a rivolgersi alle strutture private. L'assenza di liste d'attesa, la possibilità di accedere a percorsi personalizzati e a tecniche specifiche sono fattori che inducono tante coppie a privilegiare cliniche e centri privati alle strutture pubbliche. Il rovescio
della medaglia è costituito dai costi. Per le strutture pubbliche o convenzionate è previsto il pagamento di un ticket, che può costare tra i 500 e i 1500 euro circa. Nel privato i prezzi lievitano in modo considerevole. L'inseminazione artificiale, tecnica di primo livello, costa generalmente tra i 1000 e i 1200 euro, mentre l'eterologa può arrivare fino a 5-6mila euro. Le tecniche di secondo livello quali la FIVET e l'ICSI, pur con differenze tra struttura e struttura, oscillano invece tra i 3.500 e i 5.500 euro. Sono costi che per molte coppie restano proibitivi: ecco perché la concreta applicazione della nuova normativa sulla PMA è quantomai auspicabile. (R. D.).

©


La storia del "piccolo guerriero", Domenico Caliendo, non è solo la cronaca di un lutto straziante, ma rappresenta un punto di rottura che impone una riflessione profonda all'intera comunità scientifica e istituzionale. È una vicenda iniziata nel cuore dell’inverno, il 23 dicembre, e conclusasi dopo sessanta giorni di agonia il 21 febbraio, sollevando interrogativi inquietanti sulla gestione della catena dei trapianti in Italia.
Quello che doveva essere un miracolo della medicina si è trasformato in un "fallimento sistemico", dove l’errore umano e procedurale ha annullato i benefici dell’innovazione tecnologica. Domenico, due anni e quattro mesi, era affetto da una miocardiopatia dilatativa congenita, una patologia severa che rende il trapianto l’unica opzione terapeutica risolutiva.
Dopo il ricovero avvenuto il 23 dicembre, la speranza si era accesa con l'individuazione di un donatore compatibile a Bolzano. Tuttavia, il passaggio dalla speranza alla tragedia è avvenuto durante il trasferimento dell'organo verso la struttura ospedaliera Monaldi di Napoli. Secondo quanto emerso dalle indagini condotte dai carabinieri del NAS guidati dal colonnello Alessandro Cisternino e dalla Procura di Napoli retta dal Procuratore Nicola Gratteri (l’inchiesta affidata al sostituto procuratore Giuseppe Tittaferrante con il procuratore aggiunto Antonio Ricci), il cuore
di Domenico è arrivato a destinazione compromesso in modo irreversibile.
Il termine tecnico emerso dalle informative è agghiacciante: un "cuore bruciato". La causa risiederebbe in una gestione errata della "catena del freddo". Invece del ghiaccio naturale o sintetico, utilizzato per mantenere l’organo in ischemia fredda a circa 4°C, sarebbe stato impiegato ghiaccio secco (anidride carbonica solida).
Il ghiaccio secco raggiunge temperature di -78,5°C, un freddo siderale incompatibile con la vita cellulare di un organo umano. In questo contesto, la biologia clinica e la medicina dei trapianti si interrogano sui protocolli di validazione.
Il ruolo dei biologi e dei patologi è cruciale: spetta a loro l'ispezione dei marker biochimici di danno miocardico e la valutazione della vitalità cellulare. L’organo è giunto a Napoli inglobato in un blocco di ghiaccio; i chirurghi hanno dovuto attendere circa 20 minuti solo per estrarlo e procedere al decongelamento. La cristallizzazione intracellulare, un fenomeno biologico devastante indotto dal gelo estremo, avrebbe causato la lisi delle membrane cellulari, rendendo il muscolo cardiaco una massa inerte.
L’aspetto più controverso dell’intera vicenda riguarda la dotazione tecnologica. Il Monaldi è un centro di eccellenza dotato (dal 2024) di dispositivi Organ Care System (OCS), che permettono la perfusione ossigenata e il monitoraggio costante della temperatura. Eppure, per il trasferimento da Bolzano, è stata utilizzata una box passiva di tipo tradizionale e obsoleta. Le indagini, anche gli audit interni del Monaldi, suggeriscono che vi fosse una grave carenza nella formazione del personale, non ancora addestrato all'uso delle tecnologie di ultima generazione.
Come sottolineato dall’avvocato della famiglia, Francesco Petruzzi, resta da chiarire «perché un centro di tale livello abbia permesso che un organo vitale viaggiasse in condizioni tecniche così precarie». Nonostante i sospetti immediati sull'integrità dell'organo, l'equipe medica ha deciso di procedere comunque con il trapianto poiché il cuore originario di Domenico era già stato espiantato e non vi erano alternative immediate. Il nuovo cuore, tuttavia, non ha mai ripreso a
battere autonomamente.
Per due mesi, Domenico è rimasto attaccato all’ECMO (Extracorporeal Membrane Oxygenation), una tecnica di supporto vitale avanzata che ha sostituito le funzioni del suo cuore inerte. È stato un periodo di attesa estenuante, durante il quale, paradossalmente, il 17 febbraio si era reso disponibile un altro cuore compatibile.
Tuttavia, il fisico del bambino era ormai troppo compromesso per sopportare un secondo intervento. Quel cuore ha poi ridato speranza a un altro piccolo paziente a Bergamo, a dimostrazione che il sistema dei trapianti, sebbene in questo caso abbia mostrato una falla fatale, resta un pilastro vitale della medicina moderna. Il 20 febbraio, di comune accordo tra medici e famiglia di Domenico, le terapie sono state sospese per evitare l'accanimento terapeutico.
La magistratura indaga ora per omicidio colposo con sei avvisi di garanzia già notificati. Ma il legale della famiglia Petruzzi ha dichiarato: «Dall'esame della cartella clinica ci sono tutti i presupposti per configurare il dolo eventuale, che comporta l'omicidio volontario». L’autopsia fornirà in ogni caso dati istopatologici essenziali, analizzati dai biologi legali, per comprendere l’esatta entità del danno d’organo iniziale.
Per i professionisti del settore, la vicenda di Domenico deve tradursi in un impegno verso l'ottimizzazione dei processi di screening: non basta la compatibilità immunologica, la qualità biologica dell'innesto è il presupposto imprescindibile.
Mentre l'inchiesta segue il suo corso, la madre di Domenico, Patrizia Mercolino, ha annunciato la nascita di una fondazione intitolata al figlio: «Ora è un angioletto - dice tra le lacrime - ma non dovremo mai dimenticarlo. Anche per questo creeremo una fondazione a lui intitolata, per aiutare i bambini che si trovino nelle sue stesse condizioni».
L'obiettivo è trasformare il dolore in un presidio di controllo, affinché la ricerca progredisca e i protocolli di assistenza vengano blindati contro la negligenza.
La storia di Domenico deve diventare il catalizzatore per un’ottimizzazione dei processi: la vita di un bambino non può dipendere da una manciata di ghiaccio secco.
Per il biologo che opera nell'ambito dei trapianti, il caso del piccolo Domenico richiama l'attenzione sulla necessità di implementare sistemi di monitoraggio sempre più sofisticati, come le tecniche di perfusione ex vivo, che permettono di valutare la funzionalità dell'organo in un ambiente controllato prima del trapianto, riducendo il rischio di primary graft dysfunction (PGD).
Sotto la lente degli inquirenti non c’è solo l’atto chirurgico, ma la filiera del trasporto: l’uso di ghiaccio secco al posto del ghiaccio umido ha causato il congelamento del cuore, rendendolo un "organo bruciato".
Il dato più inquietante emerso dalle indagini riguarda la dotazione tecnologica: l’ospedale Monaldi pare avesse già in dotazione box di ultima generazione per il trasporto monitorato, ma per il prelievo a Bolzano sarebbe stata utilizzata una box obsoleta, priva di sensori termici e sistemi di isolamento avanzati.
Questo paradosso - avere la tecnologia ma non impiegarla - ha trasformato una procedura di eccellenza in un fallimento sistemico. Se fosse stato seguito un protocollo di validazione biologica rigido all'arrivo dell'organo, i parametri biochimici avrebbero
probabilmente mostrato un danno cellulare incompatibile con la vita. Il ruolo del biologo è fornire al chirurgo dati oggettivi per dire: «Questo organo non è biologicamente idoneo», evitando il rischio di procedere con un impianto senza speranza.
Per il biologo operante nei centri trapianti, questo evento infausto richiama la necessità impellente di implementare sistemi di monitoraggio sofisticati e protocolli rigidi. Non è più accettabile l'uso di contenitori passivi che affidino alla discrezionalità umana la gestione di temperature critiche.
La tecnologia OCS (Organ Care System) e le tecniche di perfusione ex vivo rappresentano oggi lo standard di sicurezza necessario: queste metodiche permettono di mantenere l'organo in uno stato fisiologico semipulsante, consentendo di valutarne la funzionalità metabolica e biochimica prima dell'impianto, riducendo drasticamente il rischio di Primary Graft Dysfunction (PGD).
La biologia clinica deve farsi garante di una «certificazione di qualità» dell'organo che sia indipendente dalle variabili logistiche. L'autopsia dovrà chiarire l'entità del danno cellulare subito dai miociti, ma il verdetto etico è già scritto: l'innovazione tecnologica è un requisito di sicurezza.
ÈImmunologia e Tipizzazione (HLA)
il compito più critico. Il biologo analizza il complesso maggiore di istocompatibilità (HLA).
Cross-match: Esegue test di compatibilità in tempo reale tra il siero del ricevente e i linfociti del donatore per escludere la presenza di anticorpi preformati che causerebbero un rigetto iperacuto (spesso fatale in pochi minuti).
Screening anticorpale: Monitora costantemente i pazienti in lista d'attesa per identificare eventuali sensibilizzazioni che potrebbero limitare le probabilità di trapianto.
Valutazione della Viabilità e del Danno Cellulare Nel caso di Domenico, questo è il punto dove la biologia clinica diventa centrale.
Analisi dei biomarcatori: Il biologo valuta i marker di citolisi (come le troponine per il cuore o le transaminasi per il fegato) che indicano se l'organo ha subito danni durante la fase di agonia del donatore o durante l'ischemia.
Perfusione ex vivo: I biologi gestiscono le macchine da perfusione che mantengono l'organo in vita fuori dal corpo. Qui monitorano parametri come il lattato, il pH e il consumo di glucosio per determinare se l'organo sta "recuperando" o se è troppo danneggiato per essere impiantato.
Sicurezza Infettivologica
Il biologo molecolare e il microbiologo de -
vono garantire, in tempi record (spesso poche ore), che il donatore non trasmetta patogeni pericolosi (HIV, Epatiti, CMV, o batteri multiresistenti). L'uso delle tecniche NAT (Nucleic Acid Testing) permette di ridurre il "periodo finestra" infettivo, aumentando la sicurezza del ricevente.
Conservazione e Catena del Freddo
Il biologo è responsabile della validazione dei protocolli di conservazione.
Soluzioni di preservazione: Studia e gestisce le soluzioni elettrolitiche ipertoniche che servono a "fermare" il metabolismo cellulare senza causare edema o lisi.
Validazione dei sistemi di trasporto: Come evidenziato dal caso del Monaldi, il biologo deve certificare che i contenitori (box) e i mezzi refrigeranti utilizzati mantengano l'organo in un range di temperatura rigoroso (solitamente 4 +-2°C), evitando sia il riscaldamento che, come purtroppo accaduto, il congelamento da ghiaccio secco.
Ricerca e Ingegneria Tissutale
Oltre la routine clinica, il biologo lavora alla frontiera della medicina:
Decellularizzazione: Ricerca su come "pulire" organi non idonei per usarli come impalcature biologiche da ricolonizzare con cellule del paziente.
Xenotrapianti: Studio della compatibilità tra organi animali (suini geneticamente modificati) e umani.

Il caso del piccolo Tommaso, il bambino napoletano che ha ricevuto un trapianto di cuore rivelatosi poi danneggiato, sta scuotendo l'opinione pubblica e accendendo i riflettori sulla tenuta del sistema trapiantologico italiano. Il timore principale, espresso chiaramente dal Ministro della Salute Orazio Schillaci, è il cosiddetto "effetto rebound": una brusca frenata delle donazioni alimentata dalla sfiducia e dal timore dei cittadini.
«Bisogna capire cosa è successo per non far perdere la fiducia verso un atto di grande altruismo», ha dichiarato Schillaci, sottolineando come la trasparenza sia l’unico antidoto alla paura. Il rischio è che un singolo evento critico possa vanificare anni di campagne di sensibilizzazione che hanno portato l'Italia a toccare vertici di eccellenza nel settore.
I primi segnali, seppur contenuti, sono già visibili. Secondo i dati forniti dall’Aido (Associazione Italiana per la Donazione di Organi), nell'ultima settimana di metà febbraio si è registrata una leggera flessione delle adesioni e qualche revoca di consensi precedentemente accordati. Flavia Petrin, presidente dell'associazione, getta però acqua sul fuoco: a fronte di 1,5 milioni di soci, le disdette degli ultimi giorni si contano nell'ordine di una decina. Un dato che non desta allarme immediato, ma che impone vigilanza, considerando che a gennaio si era registrato un "boom" con 4.500 nuove adesioni. La sfida comunicativa è ora quella di bilanciare il dolore per la vicenda di Tommaso con la realtà di un sistema che, nel solo 2024, ha superato i 4.500 trapianti eseguiti con successo.
Attualmente, circa 8.000 persone restano in lista d'attesa, sperando in quel "sì" che può cambiare il destino di intere famiglie. A sostegno del valore della donazione è intervenuto anche Reginald Green, padre del piccolo Nicholas, il cui gesto nel 1994 rivoluzionò la cultura del dono in Italia.
Dall'alto dei suoi 97 anni, Green ricorda come ogni famiglia in lutto abbia il potere di trasformare una tragedia in vita: «La storia di Tommaso ci ricorda quanto sia preziosa ogni donazione». Il messaggio delle istituzioni e del mondo del volontariato è univoco: l'errore o la fatalità non devono oscurare l'efficacia di un sistema che restituisce ogni anno migliaia di cittadini alla vita produttiva e sociale. (M. A.).
© H_Ko/shutterstock.com

A Milano, il convegno della Fnob dedicato alla medicina di laboratorio
D’Anna «La nuova veste della nostra professione è più vicina alle esigenze dei professionisti»

La professione del biologo in Italia sta vivendo una fase di profonda e storica trasformazione, caratterizzata da una maggiore autonomia, un riconoscimento ampliato delle competenze e prospettive occupazionali in forte crescita. Questo cambiamento epocale è stato illustrato dal Presidente della Federazione Nazionale degli Ordini dei Biologi (FNOB), Vincenzo D’Anna, che ha delineato il percorso di evoluzione della categoria in apertura dei lavori del convegno dal titolo “Medicina di laboratorio: qualità, innovazione e sostenibilità”, organizzato il 10 febbraio scorso a Milano, presso la Casa del Cardinale Ildefonso Schuster.
La riforma ha segnato il passaggio da un ordine centralizzato a una struttura basata su ordini territoriali, una scelta strategica per garantire una rappresentanza più efficace e vicina alle esigenze locali. «I biologi non potevano continuare a essere esclusi dalle professioni sanitarie, ma vi dovevano essere inseriti a pieno titolo» ha dichiarato D’Anna, sottolineando come l’ordine centralizzato potesse favorire “cricche di potere” a discapito della volontà degli iscritti. Questa transizione ha conferito ai biologi la facoltà di eleggere i propri dirigenti e di definire attività e prospettive specifiche per il proprio territorio, riconoscendo che le problematiche di un biologo a Trapani sono diverse da quelle di un biologo a Milano. Un pilastro fondamentale di questa “rifondazione” è rappresentato dai futuri decreti della legge 161/2021 sulle lauree abilitanti. Questi riepilogheranno le competenze dei biologi, superando la genericità della legge originaria del 1967 che non esplicitava discipline moderne come la genetica, la genomica, la nutrizione o la bioinformatica. La professione sarà separata in tre ambiti distinti: biologi generali e sanitari, biologi ambientali e biologi nutrizionisti, garantendo finalmente una chiara declaratoria di competenze e una certezza giuridico-legislativa finora carente. Le statistiche confermano il successo di questa evoluzione: i biologi, insieme ai matematici, vantano il maggior indice di occupazione professionale, con un incremento del 14%. I nuovi decreti aprono inoltre a campi innovativi nella medicina di laboratorio, come la medicina di precisione, predittiva e personalizzata, offrendo prospettive che superano quelle mediche in termini di innovazione. La biologia spaziale è un altro grande settore in espansione. In generale i biologi oggi possono svolgere fino a 80 diverse tipologie di attività.
Il Presidente D’Anna ha espresso grande orgoglio e rivendicato il ruolo della FNOB per aver contribuito a superare un passato in cui i biologi erano considerati “figli di un Dio minore” o “fratelli scelti dei medici”, soggetti a fenomeni di “apartheid” professionale. Ha esortato la categoria a non cadere nella “trappola” del campanilismo e del nazionalismo, definiti “l’ultimo rifugio di un briccone”, ma a lavorare per l’unità basata su sapienza, afflato, entusiasmo e intelligenza. La Federazione, ha ribadito, è qui per “aiutare, consigliare, tutelare”, senza interferire con l’autonomia degli ordini territoriali. Questa rivoluzione non solo rafforza la posizione dei biologi nel panorama professionale italiano, ma li proietta verso un futuro di nuove sfide e opportunità, consolidando il loro ruolo insostituibile nella scienza e nella società. (M. A.).


Dalla biologia molecolare alla biopsia liquida: le nuove frontiere della medicina di precisione nella lotta al tumore al colon che ha colpito l’attore a soli 48 anni
di Matilde Andolfo

La notizia della sua scomparsa, avvenuta l’11 febbraio, ha scosso l’opinione pubblica e, in breve tempo, ha fatto il giro del mondo. James Van Der Beek, l’indimenticabile Dawson dell’iconica serie TV, se n’è andato a soli 48 anni a causa di un cancro al colon-retto. Una malattia che lo stesso attore aveva reso nota nel 2023, scoperta quasi per caso durante un banale controllo di routine.
Colpisce la dimensione umana di questa tragedia, che ha coinvolto una famiglia numerosa trovatasi ad affrontare non solo il dolore, ma anche le ingenti difficoltà economiche legate alle cure. La solidarietà non è mancata: la raccolta fondi avviata dopo la sua morte ha raggiunto il milione di euro in pochi giorni, con donazioni arrivate anche da giganti del cinema come Steven Spielberg.
Restano le immagini potenti di un uomo che non si è mai piegato. James ha affrontato mesi difficili con una
dignità rara, circondato da sprazzi di luce e dall'affetto dei suoi cari.
Indimenticabile resterà l'evento di beneficenza “Dawson’s Creek Class Reunion” dello scorso settembre: mentre la moglie Kimberly e i sei figli cantavano sul palco la storica sigla della serie - "I Don't Want to Wait" di Paula Cole - James, assente per un'infezione, inviava un video colmo di speranza.
Le ultime settimane sono state un mosaico di tenerezza e di potenza: gli scatti sulla sedia a rotelle davanti al tramonto e la carezza finale dell'amico di sempre, Alfonso Ribeiro, il mitico Carlton della serie Willy, il principe di Bel-Air, accorso al suo capezzale. Oggi, dopo il ringraziamento della moglie Kimberly che ha chiesto un rispettoso silenzio, resta la sua eredità umana e un monito per tutti noi.
Il caso di Van Der Beek è lo specchio di un mutamento preoccupante: un uomo giovane, sportivo e senza familiarità per la patologia, colpito

da un adenocarcinoma allo stadio 3. I dati dell'American Cancer Society parlano chiaro: l'incidenza di questo tumore negli under 50 cresce dell'1-2% ogni anno dalla metà degli anni '90.
La ricerca oggi indaga su nuovi colpevoli: alterazioni del microbiota intestinale, esposizione precoce alle microplastiche, ceppi di Escherichia coli che producono colibactina, una tossina capace di danneggiare il DNA.
La testimonianza di James Van Der Beek è diventata un potente manifesto sulla necessità di non ignorare i sintomi, anche quando si è nel pieno della giovinezza, e sottolinea quanto sia cruciale abbassare la soglia di attenzione e anticipare i controlli se il corpo lancia dei segnali. Ecco perché in questo numero proveremo a dare risposte coinvolgendo la medicina ma anche la biologia.
Il futuro della lotta contro il cancro risiede nella biologia molecolare. Se i controlli tradizionali restano il "gold standard", la vera svolta è rappresentata dalla biopsia liquida, capace di intercettare frammenti di DNA tumorale nel sangue molto prima che i sintomi diventino evidenti.
I DATI DELL'AMERICAN CANCER
SOCIETY PARLANO CHIARO:
L'INCIDENZA DI QUESTO TUMORE
NEGLI UNDER 50 CRESCE
DELL'1-2% OGNI ANNO
DALLA METÀ DEGLI ANNI '90

Il tumore del colon-retto non è più solo una patologia dell'età avanzata. Tra stili di vita moderni e l'importanza vitale dello screening, facciamo chiarezza su come riconoscere i segnali e intervenire in tempo. L'intervista al professor Luigi Pasquale, direttore dell’UOC Gastroenterologia Ospedale Monaldi di Napoli.
Professore, quali sono i sintomi più comuni a cui dobbiamo prestare at tenzione?
«Il corpo ci invia segnali precisi, ma è fondamentale che questi siano persistenti per destare reale allarme. I campanelli d'allarme principali includono la presenza di sangue nelle feci (sia rosso vivo che scuro), dolori addominali ricorrenti, un’improvvisa alterazione delle abitudini intestinali - come stitichezza o diarrea prolungata, o l'alternanza tra le due - e un'anemia da carenza di ferro non altrimenti spiegata».
Un tempo si pensava fosse un tumore "da anziani". È ancora così?
«Tradizionalmente sì, l’età media alla diagnosi superava i 60 anni. Tuttavia, stiamo assistendo a un fenomeno preoccupante: l'aumento dei casi tra i soggetti sotto i 50, e talvolta anche sotto i 40 anni. È un incremento numericamente contenuto ma significativo, perché
coinvolge generazioni che un tempo non erano considerate a rischio. Il problema principale è psicologico: a 35 anni raramente si sospetta una neoplasia del colon, ritardando così la diagnosi».
Si parla spesso di "tumore silenzioso". Cosa succede all'interno dell'intestino?
«Esatto. Nelle fasi iniziali è quasi sempre asintomatico. Nel 90% dei casi, tutto ha origine da un polipo intestinale, chiamato adenoma. È un processo lento: dalla formazione del polipo alla comparsa del carcinoma passano circa sette anni, e ne servono altri tre perché si sviluppino metastasi. Identificare e rimuovere un polipo durante una colonscopia significa, di fatto, prevenire il tumore prima ancora che nasca».
Quanto pesano le nostre abitudini quo tidiane e quanto conta la familiarità?
«L'ambiente gioca un ruolo chiave. Negli ultimi vent’anni il nostro stile di vita è peggiorato: l’aumento di obesità, il consumo di alcol, carni rosse e cibi ultra-processati, uniti a una drastica riduzione delle fibre, hanno creato un terreno fertile per la malattia.
Esiste poi una componente genetica: sindromi specifiche o una semplice suscettibilità familiare aumentano il rischio. Anche patologie infiammatorie croniche come il Morbo di Crohn o la
rettocolite ulcerosa richiedono un monitoraggio più stretto. Chi ha familiari colpiti da polipi o tumori dovrebbe parlarne subito con il proprio medico per un piano di prevenzione personalizzato».
In Italia come funziona il protocollo di prevenzione?
«Lo screening nazionale offre gratuitamente il test del sangue occulto fecale tra i 50 e i 70 anni. È un esame semplice che va eseguito senza timore. Se il risultato è positivo, si procede con la colonscopia: un passaggio fondamentale che permette non solo la diagnosi, ma spesso la guarigione immediata tramite la rimozione delle lesioni precancerose».
Se la diagnosi è confermata, la chirur gia è l'unica strada?
«La chirurgia resta il pilastro del trattamento, ma oggi è molto meno invasiva. Utilizziamo tecniche laparoscopiche o robotiche che riducono i tempi di recupero. Il percorso è poi multimodale: in base all'esame istologico, possiamo integrare chemioterapia, radioterapia o immunoterapia. In alcune situazioni chemio e radio vengono eseguite prima dell’intervento. Anche situazioni che vent’anni fa apparivano disperate, oggi possono essere affrontate con ottime prospettive grazie a cure sempre più personalizzate». (M. A.).

Il professor Luigi Pasquale è un'eminenza nel campo della gastroenterologia e dell'endoscopia digestiva italiana. Dal 16 febbraio 2024, ricopre il ruolo di Direttore della UOC di Gastroenterologia ed Endoscopia Digestiva presso l'AORN Ospedali dei Colli - Monaldi di Napoli.
La sua carriera è strettamente legata alla Società Italiana di Endoscopia Digestiva (SIED), di cui è stato Presidente Nazionale nel quadriennio 2018-2022. In questo ambito ha ricoperto ruoli di vertice, tra cui:
Direttore del Corso Nazionale Annuale SIED (2022-2024), Coordinatore del Comitato Scientifico SIED-AGENAS (2018-2022), Responsabile Amministrativo e Segretario Nazionale/Tesoriere (2016-2018).
Prima del prestigioso incarico al Monaldi, il professor Pasquale ha diretto per anni la stessa unità operativa presso l’ASL di Avellino (P.O. Ariano Irpino), dove è stato anche responsabile clinico per lo screening del cancro del colon-retto tra il 2006 e il 2009.
È noto per il suo impegno nella divulgazione scientifica e nella formazione, partecipando regolarmente come esperto a forum medici e iniziative di prevenzione.
GUIDA PRATICA ALLO SCREENING IN ITALIA
In Italia, lo screening è un servizio gratuito offerto dal Sistema Sanitario Nazionale, senza bisogno di impegnativa medica.
• Il Test (SOF): Ricerca del sangue occulto nelle feci. È un kit semplice da usare a casa e consegnare in farmacia o ai centri ASL.
• Target Standard: Generalmente offerto ogni 2 anni a uomini e donne tra i 50 e i 70 anni.
• Informazioni Regionali: Ogni Regione gestisce il proprio programma. Puoi trovare i dettagli specifici sulla guida di Fondazione AIRC agli screening regionali o sui portali dedicati come Salute Lazio e ATS Milano.
• Casi Speciali: Se hai familiarità (parenti di primo grado colpiti) o patologie infiammatorie, lo screening deve iniziare prima dei 45-50 anni su consiglio del gastroenterologo.
PREVENZIONE A TAVOLA: LE LINEE GUIDA
La salute dell'intestino passa da ciò che mangiamo. Secondo le raccomandazioni di Fondazione AIRC e delle principali autorità sanitarie, la dieta è la nostra prima difesa.
Cosa privilegiare:
• Fibre (almeno 25-30g al giorno): Cereali integrali (orzo, avena, farro), legumi, frutta e verdura fresca. Le fibre accelerano il transito intestinale, riducendo il tempo di contatto tra sostanze tossiche e pareti del colon.
• Antiossidanti naturali: Alimenti come aglio e cipolla contengono composti solforati che possono migliorare il sistema immunitario e rallentare la crescita di cellule anomale.
Cosa limitare o evitare:
• Carni rosse e processate: Limitare la carne fresca (bovina, suina, ovina) a non più di 300-500g a settimana ed evitare salumi e insaccati, classificati come cancerogeni certi per il colon.
• Alcol: Anche consumi ridotti aumentano il rischio.
• Zuccheri raffinati e grassi saturi: Correlati all'infiammazione e all'obesità, fattore di rischio per oltre 13 tipi di cancro.
La prof.ssa Marangoni ci guida tra evidenze scientifiche, sicurezza e strategie innovative per modularli a vantaggio della salute
di Emanuela Birra
Negli ultimi anni, il microbioma umano è passato dall’essere un semplice oggetto di studio a un protagonista della ricerca biomedica. Si è rivelato un elemento chiave nel modulare infezioni, risposta immunitaria e salute sistemica. Questa nuova consapevolezza ha messo in discussione una visione esclusivamente "patogeno-centrica" della malattia. Ha aperto la strada a strategie terapeutiche che si basano sulla modulazione degli ecosistemi microbici.
In questo contesto, il trapianto di microbiota fecale è uno degli esempi più concreti di come la conoscenza dei microrganismi possa diventare pratica clinica, soprattutto in campo infettivologico. Oggi, a distanza di alcuni anni dai primi studi clinici, l’attenzione si è spostata dalla novità del trattamento alla valutazione della sua affidabilità, sicurezza, riproducibilità e integrazione nei percorsi terapeutici.
Per fare il punto su ciò che è stato acquisito dalla ricerca e su quali sfide restino aperte, abbiamo intervistato Antonella Marangoni, Microbiologa clinica presso il Policlinico Sant’Orsola di Bologna, dove svolge attività di ricerca e diagnostica in microbiologia. Nel corso della sua carriera, si è concentrata nello studio delle infezioni batteriche, delle interazioni tra microrganismi e ospite e del ruolo del microbioma umano nei processi patologici e terapeutici.
La sua attività scientifica ha approfondito le applicazioni cliniche del trapianto di microbiota fecale e le strategie per modulare il microbioma. Ha mantenuto un’at -
tenzione costante sulla sicurezza, sulla validazione delle evidenze e sul trasferimento dei risultati della ricerca nella pratica clinica. Ha partecipato a numerosi studi e collaborazioni scientifiche, contribuendo al dibattito nazionale e internazionale su uno dei settori più attivi della medicina moderna.
Quando si parla di trapianto di microbioma, si tende spes so a presentarlo come una terapia “innovativa”. A suo avviso, qual è l’aspetto davvero rivoluzionario di questo approccio dal punto di vista scientifico e clinico?
Più che l’atto tecnico del trapianto in sé, l’aspetto davvero rivoluzionario del trapianto di microbiota fecale è il cambio di paradigma che introduce. Per la prima volta, in ambito clinico, non interveniamo su un singolo patogeno o su una specifica via molecolare, ma su un ecosistema biologico complesso.
È interessante notare come questa apparente “novità” abbia in realtà radici antiche: pratiche riconducibili al trasferimento di materiale fecale vengono già descritte nell’antica medicina cinese: infatti, abbiamo una testimonianza del IV secolo d.C. di un medico chiamato Ge Hong che prescriveva una “zuppa gialla” a base di feci umane per la cura di intossicazioni o diarree severe. Ciò che è cambiato oggi è la cornice scientifica che ci consente di comprenderne - almeno in parte - i meccanismi, di valutarne l’efficacia e di discuterne criticamente i limiti.
Dal punto di vista clinico, il trapianto di microbiota fecale o FMT (Fecal Microbiota Transplanation) ha mostrato

che ripristinare una funzione ecologica, più che eliminare un agente, può essere terapeuticamente decisivo. In questo senso, non è solo una terapia innovativa, ma un banco di prova per una medicina che integra ecologia microbica, fisiologia dell’ospite e pratica clinica.
In quali condizioni cliniche il trapianto di microbiota può oggi essere considerato una strategia terapeutica solida, supportata da evidenze sufficienti, e dove invece la ricer ca è ancora in una fase esplorativa?
Oggi è possibile distinguere con relativa chiarezza tra ambiti in cui il trapianto di microbiota fecale può essere considerato una strategia terapeutica solida e altri in cui la ricerca è ancora esplorativa. L’indicazione con il livello più alto di evidenza rimane l’infezione ricorrente da Clostridioides difficile, dove l’FMT agisce efficacemente come ripristino di una funzione ecologica fondamentale, la colonizzazione-resistenza. In questo contesto, l’effetto clinico è robusto e riproducibile.
Accanto a questo, stanno emergendo dati incoraggianti sull’uso dell’FMT in disbiosi severe associate a colonizzazione e/o infezioni da batteri multiresistenti, soprattutto in pazienti fragili. Anche qui il razionale è in primis ecologico: ristabilire una comunità microbica complessa può ridurre la persistenza dei patogeni e la probabilità di reinfezione, sebbene le evidenze siano meno standardizzate e forti rispetto a quelle relative a C. difficile.
In altre condizioni, come le malattie infiammatorie croniche intestinali - in particolare la rettocolite ulcero -

IL MICROBIOMA UMANO È PASSATO
DALL’ESSERE UN SEMPLICE OGGETTO DI STUDIO
A UN PROTAGONISTA DELLA RICERCA BIOMEDICA. SI È RIVELATO UN ELEMENTO CHIAVE NEL
MODULARE INFEZIONI, RISPOSTA IMMUNITARIA E SALUTE SISTEMICA
sa - i segnali di efficacia esistono, ma sono più eterogenei e fortemente dipendenti da variabili chiave: la selezione del donatore, la modalità di preparazione del materiale, la via e la frequenza di somministrazione, nonché il profilo microbiologico e immunologico di partenza del paziente.
Infine, per disturbi funzionali intestinali e per le indicazioni extra-intestinali (metaboliche, neurologiche, immunologiche), il razionale biologico è spesso convincente, ma le evidenze cliniche restano frammentarie. In questi casi, la sfida principale è distinguere correlazioni microbiota-fenotipo da reali relazioni causali e capire se l’FMT sia lo strumento più adatto o solo una tappa verso interventi microbici più definiti.
Nel suo percorso di ricerca, quali studi o ri sultati ritiene abbiano contribuito in modo più significativo a chiarire il ruolo del mi crobioma nelle infezioni e nelle applicazioni cliniche del trapianto?
Nel mio percorso di ricerca sono stati particolarmente formativi alcuni studi che han -

no contribuito a ridefinire il ruolo del microbioma nella suscettibilità alle infezioni.
Tra i lavori fondamentali ricorderei innanzitutto quello di van Nood et al. (“Duodenal Infusion of Feces for Recurrent Clostridium difficile”, New England Journal of Medicine, 2013), primo studio randomizzato controllato, pietra miliare in ambito di FMT e l’articolo di Buffie et al. (“Precision microbiome reconstitution restores bile acid mediated resistance to Clostridium difficile”, Nature, 2015) sul concetto di resistenza alla colonizzazione come base ecologica della protezione contro patogeni intestinali.
Un altro riferimento cruciale per la comunità clinica è il Consensus europeo di Roma (“European consensus conference on faecal microbiota transplantation in clinical practice”, Gut, 2017), che ha codificato le indicazioni, i criteri di selezione dei donatori, le modalità di somministrazione e gli aspetti di sicurezza dell’FMT nella pratica clinica.
Infine, è fondamentale un lavoro uscito lo scorso anno, dal titolo “International Consensus Statement on Microbiome Testing in Clinical Practice” (Porcari et al., The Lancet, 2025), in cui si riflette sul tema più ampio dell’integrazione del microbioma nella pratica clinica, sottolineando la necessità di rigore metodologico, appropriatezza clinica e interpretazione funzionale dei dati microbiologici e l’attenzione che si deve porre per evitare usi distorti della mappatura del microbioma.
Con il passaggio dalla ricerca alla pratica cli nica, come è cambiato nel tempo il suo ruolo di scienziata e quali responsabilità ha senti to crescere maggiormente?
Nel mio caso, il rapporto tra ricerca e pratica clinica non è mai stato un passaggio netto, ma piuttosto un percorso intrecciato fin dai tempi di giovane specializzanda in Microbiologia e Virologia. Questo ha reso naturale concepire la ricerca non come un esercizio puramente accademico, ma come uno strumento per rispondere a bisogni clinici concreti, spesso emergenti e complessi. Con il tempo, tuttavia, è cresciuta soprattutto la responsabilità di tradurre correttamente la complessità biologica, evitando sia semplificazioni eccessive, sia promesse non

supportate dai dati. Nel campo del microbioma, dove il confine tra innovazione e hype è particolarmente sottile, il ruolo del microbiologo clinico diventa anche quello di garante del rigore: definire indicazioni appropriate, contribuire a standard condivisi e comunicare in modo onesto limiti, incertezze e potenzialità.
È fondamentale promuovere una cultura del microbioma fondata su evidenze solide, interdisciplinarità e senso critico, affinché il passaggio dalla ricerca alla clinica avvenga in modo sostenibile e realmente utile.
Per tale motivo, all’interno della società scientifica AMCLI (Associazione Microbiologi Clinici Italiani) esiste dal 2022 un gruppo di lavoro sul microbiota e ci siamo impegnati a fare uscire entro l’anno il percorso per FMT, che potrà essere di aiuto per i centri che vogliono implementare tale pratica.


Ogni innovazione terapeutica porta con sé entusiasmo ma anche rischi di semplificazione. Dove, secondo lei, è necessario oggi mantenere maggiore cautela quando si parla di trapianto di microbioma?
Oggi la cautela è necessaria soprattutto nel modo in cui il trapianto di microbiota viene raccontato e utilizzato. Il rischio principale è ridurlo a una procedura plug-and-play, come se il trasferimento di un microbioma “sano” potesse produrre effetti prevedibili e universalmente replicabili.
In realtà, il trapianto interviene su un ecosistema dinamico e altamente contestuale, profondamente influenzato dal profilo dell’ospite, e questo impone prudenza nelle aspettative e nell’interpretazione dei risultati.
È inoltre fondamentale mantenere un atteggiamento critico nell’estensione delle indicazioni cliniche: l’interesse verso applicazioni extra-intestinali o multifattoriali è scientificamente stimolante, ma deve procedere di pari passo con studi ben

disegnati, evitando di confondere correlazioni biologiche con reali relazioni causali.
Infine, la cautela riguarda anche la responsabilità collettiva della comunità scientifica. Standardizzazione, sicurezza, regolazione e comunicazione corretta sono elementi imprescindibili affinché il trapianto di microbiota non resti un’innovazione affascinante ma fragile, bensì diventi uno strumento clinico solido, inserito in una visione più ampia di medicina basata sull’ecologia dei sistemi biologici.

La professoressa Tatjana Baldovin, coordinatrice del laboratorio di Igiene e Microbiologia Applicata dell’Università di Padova, ci spiega perché il fenomeno è così diffuso e come combatterlo
di Ester Trevisan
Antibiotico-resistenza: tutti ne parlano ma in pochi la conoscono davvero. Professoressa Baldovin, spieghiamo cos’è e come si sviluppa?
L’antibiotico resistenza è un fenomeno evolutivo naturale, che avviene come forma di adattamento all’ambiente, in cui i batteri acquisiscono o selezionano mutazioni e geni che li rendono insensibili agli antibiotici. L’uso improprio o eccessivo di questi farmaci accelera la selezione di ceppi resistenti, riducendo l’efficacia terapeutica e complicando il trattamento delle infezioni.
Secondo un recente report dell’Istituto superiore di sani tà, i tassi alti di antibiotico-resistenza in Italia mostrano qualche segno di miglioramento. Ma si tratta comunque di un fenomeno ancora troppo dif fuso. Perché?
Purtroppo, nonostante gli sforzi messi in atto da anni per contrastare il fenomeno, l’antibiotico-resistenza continua a rappresentare uno dei principali problemi di Sanità Pubblica, con un forte impatto sanitario ed economico. I motivi sono diversi, in particolare legati ancora ad un uso inappropriato ed eccessivo nell’uomo, a livello zootecnico e in agricoltura, ai meccanismi biologici intrinseci dei microrganismi indotti dalla pressione selettiva e a dinamiche come la mobilità globale e la mancanza di nuove molecole antibiotiche.
È un fenomeno complesso e rappresenta una delle sfide sanitarie più importanti a livello globale.
Ogni anno miete circa 12mila vittime, pari a un terzo di tutti i decessi registrati tra i pazienti ricoverati in ospe dale. Come si può combattere questo nemico?
L’antibiotico resistenza va combattuta efficacemente attraverso azioni coordinate e multidisciplinari, adottando un approccio “One Health” che coinvolga la salute umana, animale e dell’ambiente, strettamente interconnesse e secondo una logica quanto più completa e integrata. Anche una governance di sistema, sostenuta da una leadership forte, è fondamentale per definire politiche e strategie di contrasto al problema.
Quali strategie si possono adottare per prevenirla?
Per contrastarla servono stewardship antibiotica rigorosa, diagnosi microbiologica rapida, controllo delle infezioni, igiene ospedaliera, sorveglianza epidemiologica dei ceppi resistenti, ricerca e sviluppo di nuovi vaccini e antibiotici e, infine, educazione e formazione.
Quali sono i batteri più difficili da debellare?
I batteri più difficili da debellare sono quelli che sviluppano resistenze multiple e meccanismi di adattamento avanzati. In Italia, le percentuali di resistenza alle principali classi di antibiotici per gli otto patogeni sotto sorveglianza continuano a mantenersi elevate, con criticità elevate nei Gram negativi - Klebsiella pneumoniae, Acinetobacter spp., Pseudomonas aeruginosa resistenti ai carbapenemi ed Escherichia coli multiresistente - e Gram-positivi come Staphylococcus aureus meticillina re -

sistente, Enterococcus faecium vancomicina resistente e Streptococcus pneumoniae.
Nel resto dell’Europa qual è la situazione? Ci sono Paesi che hanno messo in campo buone pratiche da cui trarre esempio?
In Europa la situazione è eterogenea, peggiore nelle regioni meridionali, centrali e orientali. I Paesi del Nord, come Svezia, Danimarca e Paesi Bassi, mostrano bassi livelli di antibiotico resistenza grazie ad un uso controllato degli antibiotici, attenta sorveglianza microbiologica e prevenzione delle infezioni. Anche Germania e Francia hanno rafforzato programmi di stewardship e monitoraggio. Queste buone pratiche dimostrano che politiche coordinate e continuità nel tempo riducono la diffusione dei ceppi resistenti.
Microscopio, batteri, virus e camice bianco erano la sua aspirazione sin da bambina oppure è stata folgorata sulla via degli studi?
La passione per il mondo microscopico c’è sempre stata, poi si è consolidata nel tempo, alimentata dallo studio e dalla curiosità scientifica per diventare, successivamente, una scelta consapevole e convinta. Più che una folgorazione, è stato un percorso fatto di interesse costante e approfondimento.
Tra attività didattica, formazione, ricerca, convegni e se minari in giro per l’Italia, riesce a trovare il tempo anche per la vita privata? E come le piace trascorrere le ore li bere dal lavoro?
Non è sempre facile conciliare tutto, ma è essenziale trovare spazi per sé e da dedicare agli altri. Il contatto diretto con la natura per me è fondamentale: stare all’aria aperta, fare escursioni e condividere il tempo libero con la famiglia e gli amici mi aiuta a recuperare le energie e a mantenere un buon equilibrio tra impegni e vita privata.
Un consiglio per i giovani biologi che vogliono dedicare la loro carriera professionale alla ricerca.
A chi desidera intraprendere una carriera nella ricerca suggerirei di coltivare curiosità e interesse, senza scoraggiarsi davanti alle difficoltà. La ricerca richiede impegno e formazione continua, perché i risultati si ottengono con la costanza e la dedizione. Rigore scientifico e spirito di squadra, inoltre, sono fondamentali per una ricerca efficace e innovativa.
I BATTERI PIÙ DIFFICILI DA DEBELLARE
SONO QUELLI CHE SVILUPPANO RESISTENZE
MULTIPLE E MECCANISMI DI ADATTAMENTO
AVANZATI. IN ITALIA, LE PERCENTUALI
DI RESISTENZA ALLE PRINCIPALI
CLASSI DI ANTIBIOTICI PER GLI
OTTO PATOGENI SOTTO SORVEGLIANZA
CONTINUANO A MANTENERSI ELEVATE

Tatjana Baldovin ha conseguito la laurea in Scienze Biologiche con orientamento biologico fisio-patologico e il dottorato all’Università di Padova. Attualmente è professoressa associata di Igiene alla Scuola di Medicina e Chirurgia dell’ateneo patavino. La sua attività di ricerca si concentra principalmente sull’epidemiologia e la prevenzione delle malattie infettive, documentata da numerose pubblicazioni su riviste internazionali. Coordina le attività del laboratorio universitario di Igiene e Microbiologia Applicata.
In questo primo scorcio di 2026
l’attenzione dei media si è concentrata su Mariano Barbacid, biochimico molecolare spagnolo e direttore del gruppo di Oncologia sperimentale del Centro Nazionale Spagnolo per la Ricerca sul Cancro (Cnio), in seguito alla pubblicazione di uno studio che presenta risultati incoraggianti nella ricerca sul cancro al pancreas. Si tratta di un ambito particolarmente complesso, caratterizzato da una mortalità elevata e da limitate opzioni terapeutiche. Per comprendere il significato di questi dati è utile analizzare il profilo dello studioso, il contesto epidemiologico della malattia e il contenuto della ricerca.
Mariano Barbacid è nato a Madrid nel 1949. Si è laureato in Chimica presso l’Universidad Complutense, per poi proseguire la sua formazione negli Stati Uniti con studi di specializzazione in biologia molecolare. Negli anni successivi ha svolto attività di ricerca in alcuni dei principali centri oncologici americani, tra cui l’MD Anderson Cancer Center di Houston.
In seguito, è stato direttore del National Cancer Institute del Maryland, incarico che ha ricoperto fino al 1998. In quell’anno è rientrato in Spagna con il compito di fondare e dirigere il Centro Nazionale Spagnolo per la Ricerca sul Cancro. Sotto la sua guida, il Cnio è diventato uno dei principali poli europei per lo studio delle malattie oncologiche.Nel corso della sua carriera, Barbacid ha pubblicato oltre 300 articoli scientifici su riviste internazionali ed è stato coinvolto in numerosi progetti
di ricerca finanziati a livello europeo e internazionale. Il lavoro di Barbacid è noto soprattutto per i contributi allo studio degli oncogeni, ovvero i geni che, in presenza di specifiche mutazioni, favoriscono la trasformazione delle cellule normali in cellule tumorali.
Nel 1982 ha partecipato all’isolamento del primo oncogene umano e all’identificazione di una mutazione direttamente associata allo sviluppo di tumori. Questa scoperta ha rappresentato un passaggio importante nella comprensione molecolare del cancro.
Successivamente ha contribuito all’isolamento dell’oncogene
Trk e allo studio di altri meccanismi genetici coinvolti nella proliferazione cellulare incontrollata. Queste ricerche hanno posto le basi per lo sviluppo delle terapie mirate, oggi utilizzate in diversi ambiti dell’oncologia.
Come è noto, il tumore al pancreas è una delle forme più aggressive. È caratterizzato da una diagnosi spesso tardiva, da una progressione rapida e da una risposta limitata ai trattamenti disponibili.

Chi è Mariano Barbacid: tutto quello che del suo studio sulla neoplasia dalla
In Italia si stimano circa 14mila nuovi casi all’anno. La sopravvivenza a cinque anni dalla diagnosi resta inferiore al 10%. La mortalità è molto elevata: nella maggior parte dei casi, il numero dei decessi è simile a quello delle nuove diagnosi annuali.
A livello globale, il cancro al pancreas colpisce oltre 500mila persone ogni anno. Nei Paesi industrializzati rappresenta una delle principali cause di morte per tumore e le proiezioni indicano un possibile aumento nei prossimi decenni, anche in relazione all’invecchiamento della popolazione.
Le opzioni terapeutiche attuali comprendono chirurgia, chemioterapia e, più recentemente, farmaci a bersaglio molecolare. Tuttavia, solo una minoranza dei pazienti è candidabile all’intervento chirurgico e le terapie farmacologiche mostrano spesso un’efficacia limitata nel tempo.
Il recente lavoro coordinato da Barbacid si concentra su una strategia di trattamento basata sull’uso combinato
di tre farmaci, progettati per interferire con specifici meccanismi molecolari coinvolti nella crescita tumorale. In particolare, la terapia agisce su tre bersagli: le proteine Egfr e Stat3, implicate nei processi di proliferazione cellulare, e l’oncogene Kras, mutato nella maggioranza dei casi di tumore pancreatico.
Secondo quanto riportato dagli autori della ricerca che è stata pubblicata sulla rivista Pnas, i risultati dei primi esperimenti indicano una riduzione significativa delle cellule tumorali, accompagnata da una limitata tossicità.
La risposta osservata risulta prolungata nel tempo rispetto a quanto registrato con altri approcci sperimentali
Lo studio è frutto del lavoro congiunto di diversi ricercatori del Cnio, coordinati da Barbacid insieme alla biologa Carmen Guerra: pur essendo i primi segnali incoraggianti, gli esperti sottolineano che i risultati ottenuti non consentono, al momento, un’applicazione immediata in ambito clinico. Sono necessari ulteriori studi per confermare l’efficacia e la sicurezza del trattamento e per valutarne la possibile traduzione in protocolli terapeutici per i pazienti. Negli ultimi anni, alcuni farmaci diretti contro Kras sono stati approvati per l’uso clinico, ma la loro efficacia è spesso limitata dallo sviluppo di resistenze. L’approccio combinato proposto dal gruppo spagnolo mira proprio a superare questo problema, intervenendo simultaneamente su più vie molecolari. Resta da verificare se questa strategia potrà essere confermata in studi successivi e se potrà portare a benefici concreti per i pazienti. (D. E.).
dalla

sapere e i risultati incoraggianti
mortalità ancora molto elevata

Capire come agiscono le cellule tumorali è una sfida che la ricerca ha posto da tempo in cima alla lista delle priorità. Proprio di recente si è celebrata la Giornata Mondiale del Cancro, iniziativa promossa dall’Unione Internazionale per il Controllo del Cancro e dall’Organizzazione Mondiale della Sanità per mantenere alta l’attenzione su quella che è una delle principali cause di morte nel mondo.
I numeri e le previsioni restano allarmanti, nonostante gli evidenti passi avanti compiuti negli ultimi anni: le stime riferiscono che entro il 2050 si potrebbe superare quota 35 milioni di diagnosi. Per intenderci: nel 2022 sono
state 20 milioni le persone a cui è stato diagnosticato un tumore per un totale di 9,7 milioni di decessi. La speranza, allora, passa dai nuovi studi, dalle ore trascorse in laboratorio con l’obiettivo di provare a far luce su un male che costituisce una minaccia globale. Proprio dall’Italia arriva una scoperta importante, che può segnare un punto di svolta.
Un gruppo interdisciplinare dell’Istituto Airc di Oncologia Molecolare Ets (Ifom) di Milano, dell’Università Statale di Milano e dell’Università degli Studi di Perugia, del Cnrs-Institut Curie di Parigi e dell’Istituto Officina dei materiali del Consiglio nazionale delle ricerche (Cnr-Iom) di Perugia ha messo a punto una nuova piattafor -
Possibile svolta nella lotta al cancro: sviluppata una piattaforma innovativa che apre le porte a nuove terapie
ma di microscopia fotonica integrata che consente di osservare in tempo reale come agiscono le cellule tumorali, come ricevono e trasformano gli stimoli meccanici e come le risposte a tali stimoli possono influenzare la crescita di un tumore, la sua invasività e la capacità di dare metastasi.
I risultati della ricerca, coordinata da Giorgio Scita e Brenda Green dell'Ifom e da Silvia Caponi del Cnr-Iom, sono stati pubblicati sull’autorevole rivista Advanced Science: grazie a questa intuizione, sarà possibile capire meglio come progrediscono i tumori e, di conseguenza, l’obiettivo è riuscire a ottenere nuove ed efficaci terapie per contrastarli.
Nel dettaglio, la piattaforma, che combina per la prima volta la tecnica Brillouin, in grado di misurare tramite la luce le proprietà meccaniche, e la tecnologia Raman, capace di rivelare invece le proprietà biochimiche, consente di misurare simultaneamente proprietà meccaniche e risposte biochimiche in sferoidi, ossia masse cellulari microscopiche in tre dimensioni, ottenuti da cellule di tumore del seno. Ebbene, dagli esperimenti condotti è emerso che deformazioni cicliche attivano rapidamente il gene dello stress ATF3, da cui conseguono comportamenti più invasivi. Nelle parole di Silvia Caponi, fisica del Cnr-Iom di Perugia, la portata di quanto venuto a galla: «Per la ricerca sul cancro questo progresso è fondamentale. La piattaforma rappresenta un salto di qualità nella diagnostica ottica».
«Questa tecnologia - evidenzia il direttore del laboratorio Meccanismi di migrazione delle cellule tumorali di Ifom Ets, Giorgio Scita - apre una nuova prospettiva per lo studio dei tumori in sistemi tridimensionali come gli sferoidi tumorali. Un importante passo avanti». (D. E.).



RICERCATORI DELL’IOCB DI PRAGA
SONO RIUSCITI A OSSERVARE
L’INIZIO DELLA TRASCRIZIONE
IN VITRO E HANNO DESCRITTO
UN NUOVO MECCANISMO LEGATO
AI CAP ALARMONE E ALLO STRESS CELLULARE
Gli scienziati dell’Istituto di Chimica Organica e Biochimica dell’Accademia Ceca delle scienze di Praga (IOCB) hanno identificato un meccanismo molecolare finora sconosciuto attraverso il quale può essere avviata la trascrizione delle informazioni genetiche dall’acido desossiribonucleico (DNA) all’acido ribonucleico (RNA). I ricercatori hanno focalizzato il loro studio su una specifica classe di molecole note come alarmoni, che si trovano nelle cellule di una vasta gamma di organismi e i cui livelli spesso aumentano in condizioni di stress cellulare. I risultati della ricerca sono stati pubblicati sulla rivista Nature Chemical Biology.
Come spiegano gli autori dello studio, le molecole di acido ribonucleico possono presentare alla loro estremità una serie di modificazioni chimiche, denominate “cappucci” (cap). Negli organismi eucarioti, comprese le cellule umane, il cap più classico dell’mRNA svolge un ruolo fondamentale nel garantire la stabilità della molecola e nel regolarne il destino successivo all’interno della cellula. Negli ultimi anni, tuttavia, è diventato chiaro che esistono anche cap alternativi e non canonici, sebbene la loro formazione e i meccanismi con cui si legano all’RNA rimangano solo parzialmente compresi. Questi, come spiegato nello studio, includono i cap alarmone, formati da molecole di dinucleoside polifosfato, che proteggono l’RNA cellulare nei momenti in cui la cellula è minacciata.
L’RNA con cappuccio di polifosfati dinucleosidici è stato scoperto solo di recente nei bat-
teri e negli eucarioti e rappresenta una classe di modifiche all’estremità 5’ che si differenzia dal classico cappuccio di 7-metilguanosina. Mentre il cappuccio standard serve a proteggere l’mRNA e facilitare la traduzione, i cappucci di polifosfati dinucleosidici sono spesso derivati da metaboliti cellulari. In molti organismi, inclusi batteri e cellule eucariotiche, questi cappucci vengono incorporati durante l’inizio della trascrizione quando l’RNA polimerasi utilizza un dinucleoside polifosfato come “primer” invece di un singolo nucleoside trifosfato (NTP).
Nello studio, Hana Cahová e i suoi colleghi hanno osservato la RNA polimerasi batterica e hanno studiato come questo enzima possa avviare la trascrizione utilizzando polifosfati dinucleosidici (NpN) invece dei normali mattoni dell’RNA. Negli organismi procarioti ed eucarioti, la concentrazione di dinucleosidi polifosfati aumenta drasticamente durante lo stress cellulare ossidativo o termico. L’inserimento di questi cappucci nell’RNA funge quindi da segnale o risposta a tali condizioni.
Nello studio gli autori hanno descritto per la prima volta a livello atomico come l’RNA con un cappuccio alarmone possa essere generato direttamente all’inizio della trascrizione genica. Gli scienziati hanno utilizzato una serie di modelli di DNA in combinazione con polifosfati dinucleosidici e RNA polimerasi modello proveniente dal Thermus thermophilus. Dalla ricerca è emerso che il sito di inizio della trascrizione può variare in base alla compatibilità tra il modello specifico e il polifosfato dinucleosidico. Gli scienziati hanno anche osservato che i NpN si legano attraverso un tipo di accoppiamento di basi diverso da quello tipicamente osservato.
Il lavoro, chiariscono gli autori, fornisce una spiegazione strutturale di come i polifosfati
dinucleosidici iniziano la trascrizione dell’RNA. Utilizzando dati di microscopia elettronica criogenica, il team ha mostrato come le molecole di polifosfati dinucleosidici si legano all’interno del sito attivo della RNA polimerasi, ovvero il nucleo dell’enzima dove viene trascritta l’informazione genica. Hana Cahová ha affermato: «Stiamo descrivendo qualcosa che accade realmente nelle cellule e che ora siamo in grado di osservare direttamente a livello delle singole molecole. Questo ci permette di rispondere a domande fondamentali sui processi cellulari, come ad esempio il modo in cui le cellule si adattano allo stress. L’RNA svolge un ruolo centrale in questo processo, poiché trasporta la cascata di informazioni alla base di qualsiasi risposta cellulare, ad esempio alle condizioni di pericolo causate dalla carenza di nutrienti o dallo shock termico».
L’impiego della microscopia elettronica criogenica è stato determinante per il progetto. Nella microscopia crioelettronica il campione viene studiato a temperature criogeniche e osservato nel suo ambiente nativo senza essere colorato o fissato in alcun modo. Si tratta pertanto di una tecnica particolarmente utile in biologia strutturale dove è fondamentale poter osservare le macromolecole biologiche nella loro conformazione nativa.
Tomáš Kouba, uno degli autori dello studio, ha spiegato quali sono i vantaggi della tecnica: «La microscopia elettronica criogenica ci permette di congelare le molecole biologiche in uno stato molto vicino alla loro forma naturale e quindi di determinarne la struttura tridimensionale». «Ciò ci ha permesso - ha proseguito Kouba - di guardare direttamente nei centri attivi degli enzimi e di osservarne la funzione fino al livello atomico». (S. B.).
Corso Ecm
Nutrizione Clinica in Oncologia e Pediatria
Evidenze, Esperienza e Casi reali
23 aprile 2026
Milano

4.2 Ecm

Uno studio americano ha individuato un meccanismo che consente ai batteri di trasmettere informazioni genetiche che favoriscono virulenza e multiresistenza agli antibiotici

LA RESISTENZA AGLI ANTIBIOTICI È IN AUMENTO A LIVELLO GLOBALE. I CEPPI BATTERICI STANNO DIVENTANDO SEMPRE PIÙ VIRULENTI E RESISTENTI A PIÙ TIPI DI FARMACI, LE OPZIONI
TERAPEUTICHE A DISPOSIZIONE SI STANNO RIDUCENDO
Un team di biologi dell’Università americana di Albany ha identificato nei batteri un sistema di comunicazione che permette lo scambio di informazioni genetiche e favorisce l’acquisizione di resistenze a più classi di antibiotici.
La nuova ricerca approfondisce la comprensione dei meccanismi attraverso cui i microrganismi sviluppano la resistenza a farmaci un tempo efficaci, un tema sempre più centrale e urgente per la ricerca biomedica.
Oggetto dello studio, pubblicato sulla rivista Nature Communications, è il batterio Listeria monocytogenes, presente nel suolo, nell’acqua e nella vegetazione. Questo microrganismo può contaminare numerosi alimenti, tra cui latte, verdure, formaggi molli e carni poco cotte, ed è responsabile della listeriosi, una patologia che può diffondersi anche al sangue e al cervello, dando origine a condizioni potenzialmente letali come sepsi, meningite ed encefalite.
Il nuovo studio potrebbe fornire informazioni utili per lo sviluppo di nuovi farmaci e, potenzialmente, di futuri approcci per la medicina personalizzata.
Cheryl Andam, autore responsabile dello studio e professore presso l’Università di Albany, ha affermato: «La resistenza agli antibiotici è in aumento a livello globale. I pazienti contraggono infezioni un tempo curabili, ma poiché i ceppi batterici stanno diventando sempre più virulenti e resistenti a più tipi di farmaci, le opzioni terapeutiche a disposizione si stanno riducendo».
«Nella corsa per capire come ciò avvenga –ha continuato Andam - le nostre ultime sco -

perte svelano un pezzo fondamentale del puzzle: i batteri possiedono intricate reti di comunicazione, all’interno delle quali i diversi componenti sono in grado di interagire e collaborare in modi finora sconosciuti».
Come spiegato dagli autori dello studio, nelle cellule dei batteri esistono brevi frammenti di DNA chiamati “elementi genetici mobili” che trasportano informazioni e si presentano in molte forme diverse, tutte con funzioni e strutture differenti. In genere questi elementi sono raggruppati, in base alle loro caratteristiche, in categorie come plasmidi, fagi e trasposoni.
«Prima di questo studio – rivela Andam - sapevamo che gli elementi genetici mobili di un particolare tipo potevano scambiarsi informazioni tra loro; quello che non sapevamo è che anche tipi diversi di elementi genetici mobili possono comunicare
scambiandosi frammenti di DNA, trasmettendo informazioni che aiutano l’agente patogeno a sviluppare resistenza ai farmaci e ad aumentare la trasmissibilità. Questa comprensione amplia la nostra visione della comunicazione intercellulare e anche del modo in cui gli agenti patogeni evolvono per diventare più letali».
Nello studio i ricercatori hanno analizzato sequenze di DNA estratte da 936 campioni di L. monocytogenes prelevati da pazienti affetti da listeriosi. Attraverso l’impiego di specifici programmi bioinformatici gli scienziati hanno identificato all’interno dei genomi batterici diversi tipi di elementi genetici mobili.
Per comprendere come questi elementi condividono il DNA tra loro, i ricercatori hanno creato un diagramma di rete in cui ogni elemento genetico mobile era rappresentato da un punto mentre le connessioni tra gli
elementi che condividevano sequenze di DNA simili erano indicate da linee. Identificando le sequenze di DNA di lunghezza minima e confrontandole tra i diversi elementi genetici mobili, i ricercatori sono riusciti a ricostruire lo scambio di informazioni tra i vari tipi di elementi genetici mobili.
Secondo gli autori dello studio, la scoperta cambia la comprensione di come avviene la diffusione di tratti batterici clinicamente rilevanti, compresa la resistenza agli antimicrobici. In particolare la ricerca ha dimostrato che il trasferimento di DNA tra diversi tipi di elementi genetici mobili amplia notevolmente la distribuzione e la mobilità dei geni di resistenza e dei geni di virulenza.
«Quando questi diversi tipi di elementi genetici mobili – prosegue Andam - scambiano materiale genetico, possono creare nuove combinazioni di geni che trasmettono resistenza a più classi di antibiotici: ad esempio, un elemento che trasporta tre geni di resistenza può acquisirne altri tre da un altro elemento, dando origine a un vettore con sei geni di resistenza. Le cellule batteriche che acquisiscono tali elementi possono imparare a resistere a più tipi di antibiotici, rendendo le infezioni sempre più difficili da trattare».
Oltre a contribuire allo sviluppo di farmaci più efficaci, i ricercatori auspicano che lo studio possa in futuro essere impiegato anche come strumento predittivo.
«Man mano che comprendiamo meglio i complessi meccanismi che agiscono all’interno dei diversi ceppi di un particolare patogeno – ha concluso Andam - diventa possibile prevedere con maggiore precisione il farmaco più efficace nel trattamento di un determinato ceppo. Ciò potrebbe aiutare i medici a identificare il trattamento migliore in modo più efficiente, migliorando i risultati per il paziente quando il tempo è un fattore critico».

© Gorodenkoff/shutterstock.com
UNO STUDIO DIMOSTRA
CHE QUESTE CELLULE SVOLGONO UN RUOLO FONDAMENTALE
PER LO SVILUPPO CEREBRALE
NEI PIÙ PICCOLI PRIMA DI CAMBIARE FUNZIONE CON L’AVANZARE DELL’ETÀ
Per molto tempo le cellule senescenti sono state considerate un segno inequivocabile del declino dell’organismo. Si tratta di cellule invecchiate, che hanno smesso di dividersi e non svolgono più correttamente le loro funzioni. Accumulate nei tessuti, sono associate all’invecchiamento e a numerose patologie, tra cui le malattie neurodegenerative come Alzheimer e Parkinson. Oggi, però, una nuova ricerca dimostra che queste cellule non rappresentano solo un problema: nel cervello dei bambini svolgono addirittura un ruolo positivo e fondamentale per lo sviluppo.
Lo studio, pubblicato sulla rivista Cell e condotto da un team della Icahn School of Medicine al Mount Sinai di New York, ha rivelato la presenza di cellule senescenti nel cervello di bambini sotto i cinque anni di età. Una scoperta che ribalta molte convinzioni precedenti e apre nuove prospettive sul modo in cui il cervello cresce, si organizza e invecchia nel corso della vita.
Le cellule senescenti sono cellule che, per vari motivi, entrano in uno stato di arresto permanente: non si dividono più, ma rimangono metabolicamente attive. Spesso rilasciano sostanze infiammatorie e segnali chimici che possono danneggiare i tessuti circostanti. Per questo motivo sono considerate una delle cause principali dell’invecchiamento biologico.
Negli adulti e negli anziani, l’accumulo di queste cellule è legato al deterioramento degli




organi, alla perdita di funzionalità e all’aumento del rischio di malattie croniche. Fino a poco tempo fa, si pensava che la loro presenza fosse quasi esclusivamente un fenomeno legato all’età avanzata. La nuova ricerca dimostra, invece, che la senescenza cellulare è presente anche nelle prime fasi della vita, con un significato completamente diverso. Analizzando campioni di corteccia cerebrale provenienti da 187 soggetti, ottenuti durante interventi chirurgici, i ricercatori hanno osservato chiari segni di senescenza sia nei cervelli anziani sia in quelli in via di sviluppo. Incrociando questi dati con immagini di risonanza magnetica, è stato possibile collegare le caratteristiche molecolari a quelle strutturali del cervello. Il risultato è sorprendente: nei bambini le cellule senescenti sembrano contribuire all’organizzazione delle reti neurali e alla corretta forma -
zione delle strutture cerebrali. In altre parole, aiutano il cervello a costruirsi nel modo giusto.
Secondo Anina Lund, prima autrice dello studio, questi dati confermano l’ipotesi secondo cui alcuni meccanismi biologici sono utili nelle prime fasi della vita, ma diventano dannosi con il passare del tempo. Si tratta di un fenomeno noto in biologia evolutiva come pleiotropia antagonista: un singolo gene o processo può avere effetti positivi in gioventù e negativi in età avanzata.
Un altro aspetto importante dello studio riguarda il fatto che la senescenza non ha lo stesso effetto in tutte le cellule del cervello. I ricercatori hanno osservato differenze significative tra vari tipi cellulari. Nella microglia, che rappresenta il sistema immunitario del cervello, la presenza di cellule senescenti è associata a un aumento del volume cerebrale. Questo suggerisce che, durante lo sviluppo, queste cellule possano favorire la crescita e la maturazione delle strutture nervose.
Al contrario, nei neuroni eccitatori, responsabili della trasmissione dei segnali che stimolano altri neuroni, la senescenza è collegata a una riduzione del volume. Ciò indica che lo stesso processo biologico può avere conseguenze opposte a seconda del contesto e del tipo di cellula coinvolta.
Questa complessità dimostra quanto sia delicato l’equilibrio che regola lo sviluppo cerebrale e quanto sia rischioso semplificare eccessivamente il ruolo delle cellule senescenti.
Se nei bambini la senescenza cellulare è utile, cosa cambia con l’età? Con il passare degli anni, questi stessi meccanismi sembrano perdere la loro funzione regolatrice e diventare progressivamente dannosi. Le cellule senescenti aumentano di numero, producono sostanze tossiche e contribuiscono all’infiammazione cronica del cervello. Questo ambiente favorisce la comparsa di patologie neurodegenerative, compromette la plasticità neuronale e accelera il declino cognitivo.
La scoperta ha importanti conseguenze anche dal punto di vista terapeutico. Negli ultimi anni si è discusso molto dei cosiddetti farmaci senolitici, progettati per eliminare le cellule senescenti dall’organismo. Questi trattamenti sono considerati promettenti per contrastare l’invecchiamento e alcune malattie croniche.
Tuttavia, lo studio suggerisce che intervenire in modo indiscriminato potrebbe essere rischioso, soprattutto nei più giovani. Eliminare le cellule senescenti in età precoce, infatti, potrebbe interferire con lo sviluppo cerebrale e avere effetti indesiderati.
A tal proposito, i futuri approcci terapeutici dovranno essere mirati, tenendo conto dell’età del paziente, del tipo di cellula e del contesto biologico. L’obiettivo non sarà semplicemente cancellare la senescenza, ma imparare a modularla nel modo più efficace possibile.


Perché alcuni ricordi restano impressi nella nostra mente per anni, mentre altri svaniscono in breve tempo? Questa domanda affascina gli scienziati da oltre un secolo. Oggi però, un nuovo studio dello Stowers Institute for Medical Research di Kansas City sembra poter dare una risposta sorprendente. I ricercatori del prestigioso istituto americano hanno identificato un meccanismo attraverso il quale il sistema nervoso è in grado di formare intenzionalmente strutture amiloidi per memorizzare a lungo termine le esperienze vissute. La scoperta ridefinisce la tradizionale concezione degli amiloidi, aggregati proteici spesso associati a patologie neurodegenerative, e apre la strada a nuove e promettenti strategie terapeutiche per i disturbi del sistema nervoso correlati a questi depositi di proteine.
«Volevamo capire come qualcosa di instabile, come le proteine, contribuisca a creare qualcosa di stabile e duraturo, come i ricordi che persistono per anni» ha affermato Kausik Si, direttore scientifico dello Stowers Institute». «Ora – ha proseguito il ricercatore - abbiamo la prova che esistono processi, all’interno del sistema nervoso, in grado di indurre una proteina a formare un amiloide in un momento preciso, in un luogo specifico e in risposta a una determinata esperienza».
Lo studio, pubblicato sulla rivista Proceedings of the National Academy of Sciences, si concentra sulle “proteine chaperone” del moscerino della frutta. Come si legge nella ricerca, la comunità scientifica ha pensato a lungo che la principale funzione delle proteine chaperone fosse quella di guidare altre proteine affinché raggiungessero il corretto stato di ripiegamento della loro struttura e di evitare la formazione di aggregati proteici potenzialmente pericolosi. Tuttavia, gli autori hanno identificato nel corso delle loro ricerche un tipo specifico di chaperone che svolge una funzione inaspettata: permette alle proteine di cambiare conformazione e di aggregarsi in amiloidi funzionali, strutture che aiutano il cervello a conservare i ricordi a lungo termine. «Questo amplia l’idea della capacità delle proteine di svolgere funzioni significative e suggerisce l’esistenza di un universo sconosciuto della biologia delle proteine chaperone che ci è sfuggito per molto tempo», ha affermato Si.
Gli amiloidi sono tipicamente associati a malattie neurodegenerative come l’Alzheimer, la malattia di Huntington e il Parkinson. Essi formano fibre proteiche “dannose” altamente stabili e densamente compatte che distruggono le cellule cerebrali, cancellando i ricordi del loro ospite. La scoperta della nuova proteina chaperone chiamata Funes dagli autori dello studio, ha inaspettatamente permesso di ipotizzare nuove opzioni per la cura delle malattie legate agli amiloidi. «In futuro - ha affermato Si – si potrebbe sfruttare le chaperone per rendere meno dannosi gli amiloidi tossici, oppure attivarle, per dotare il cervello di una maggiore capacità di formare amiloidi funzionali. In questo modo, si potrebbe contrastare l’accumulo degli amiloidi responsabili delle malattie neurodegenerative».
UNA NUOVA RICERCA AMERICANA
DIMOSTRA COME AVVIENE
LA FORMAZIONE DEGLI AMILOIDI FUNZIONALI, SPECIALI STRUTTURE CHE
AIUTANO LA MENTE A CONSERVARE
I DATI A LUNGO TERMINE
La scoperta fondamentale da cui è iniziato lo studio che ha portato all’identificazione di Funes è avvenuta nel 2003 quando Si individuò per la prima volta l’esistenza di un amiloide funzionale nella lumaca di mare. Nel nuovo studio gli autori hanno dimostrato che Funes è una componente essenziale per la formazione della memoria a lungo termine nel moscerino della frutta, ma non solo in questo piccolo insetto. «Stiamo ottenendo le prime prove che il processo potrebbe manifestarsi anche nel sistema nervoso dei vertebrati», ha detto Si. «La nostra ipotesi – ha proseguito l’autore - sul ruolo delle chaperone nella formazione controllata di amiloidi funzionali per la conservazione della memoria potrebbe valere anche per il cervello dei vertebrati, suggerendo che si tratti di un meccanismo universale».
Durante lo screening delle proteine chaperone, il team dello Stowers ha fatto un’altra scoperta inaspettata. Funes era la più sorprendente, ma non l’unica proteina chaperone ad influenzare la memoria. «Se si osservano le versioni umane di questi geni, essi sono stati sorprendentemente associati alla schizofrenia negli studi di associazione genomica», ha affermato Kyle Patton, autore principale dello studio. Patton ha sottolineato che questa sovrapposizione non implica che la schizofrenia sia una “malattia delle chaperone”, ma suggerisce che queste proteine potrebbero svolgere un ruolo chiave. «In definitiva – ha concluso Si - le chaperone potrebbero permettere al cervello di percepire, elaborare e memorizzare informazioni sul mondo esterno. E in malattie in cui la percezione della realtà è alterata, come la schizofrenia o il disturbo bipolare, è plausibile ipotizzare che le chaperone possano avere un ruolo significativo». Gli autori ritengono straordinario il fatto che oggi possiamo ipotizzare nuovi approcci terapeutici per le patologie umane, partendo dallo studio di organismi relativamente semplici rispetto a noi, come la lumaca di mare. (S. B.).

Studio dell'University College mostra come il cervello colpito dalla malattia provi nel sonno a riprodurre le esperienze recenti, ma lo fa in modo disordinato e confuso
di Elisabetta Gramolini
Nuovi test per una diagnosi precoce e trattamenti farmacologici
mirati potrebbero essere sviluppati grazie a uno studio, pubblicato sulla rivista Current Biology, che si è concentrato sul processo che compie il cervello malato di Alzheimer durante il riposo.
I ricercatori dell'University College di Londra hanno analizzato la disfunzione mnemonica nella malattia e sono giunti all’ipotesi che possa essere collegata a un deterioramento del modo in cui il cervello ripercorre le esperienze recenti nel sonno. La memorizzazione a lungo termine, infatti, normalmente non avviene mentre siamo nel pieno dell'azione, bensì quando ci riposiamo.
Nell’ippocampo, una regione cerebrale fondamentale per la memoria e l’orientamento spaziale, risiedono le cosiddette cellule di posizione. Scoperte dal neuroscienziato premio Nobel della stessa università, il professor John O'Keefe, queste cellule sono neuroni (cellule cerebrali) che rappresentano luoghi specifici. Quando visitiamo un luogo, particolari cellule di posizione si attivano. Successivamente, quando riposiamo, le cellule si riattivano nella stessa sequenza, contribuendo a radicare i ricordi. Con una metafora, questi neuroni agiscono come un GPS biologico, in sequenze specifiche mentre ci muoviamo in un ambiente.
Quando dormiamo, il cervello mette in atto il meccanismo del replay, riattivando quelle stesse sequenze neuronali in modo rapido e ordinato. Nel lavoro, gli autori hanno osservato cosa accade quando questo meccanismo si guasta per colpa della malattia di Alzheimer. I risultati hanno evidenziato come il cervello tenti ancora di consolidare le esperienze recenti, ma le sequenze di impulsi nervosi perdano la loro coerenza strutturale.
I neuroni - che dovrebbero attivarsi in un ordine logico e cronologico - iniziano a sparare in modo disordinato, così come farebbe un nastro che salta o si aggroviglia in un vecchio lettore Vhs.
«Il morbo di Alzheimer – ha dichiarato Sarah Shipley, principale co-autrice, nella nota diffusa dall’Università – è causato dall'accumulo di proteine e placche dannose nel cervello, che portano a sintomi come la perdita di memoria e la difficoltà di navigazione, ma
non è ancora del tutto chiaro come queste placche interferiscano con i normali processi cerebrali. Volevamo capire – ha aggiunto – come la funzione delle cellule cerebrali cambi con lo sviluppo della malattia, per identificare cosa determina questi sintomi.
Quando riposiamo, il nostro cervello normalmente ripercorre le esperienze recenti: si ritiene che questo sia fondamentale per la formazione e il mantenimento dei ricordi. Abbiamo scoperto che questo processo di ripercussione si interrompe per sviluppare le placche amiloidi caratteristiche dell'Alzheimer, e questa interruzione è associata alle scarse prestazioni nei compiti di memoria».

L'obiettivo dei ricercatori è ora quello di indagare se, intervenendo sui livelli di acetilcolina, sia possibile "raddrizzare" il replay difettoso, restituendo ordine alle sequenze neuronali e migliorando così l'efficacia dei trattamenti. «Abbiamo scoperto – ha spiegato Caswell Barry, co-autore – un'anomalia nel modo in cui il cervello consolida i ricordi, visibile a livello dei singoli neuroni. Ciò che colpisce è che gli eventi di ripetizione si verificano ancora, ma hanno perso la loro struttura normale.
Non è che il cervello smetta di cercare di consolidare i ricordi; è il processo stesso ad aver subito un errore. Ci auguriamo che le nostre scoperte possano contribuire allo sviluppo di test per la diagnosi precoce dell'Alzheimer, prima che si verifichino danni estesi, o portare a nuovi trattamenti mirati a questo processo di ripetizione. Stiamo ora studiando – ha concluso – se possiamo manipolare la ripetizione attraverso il neurotrasmettitore acetilcolina, già bersaglio dei farmaci utilizzati per trattare i sintomi dell'Alzheimer. Comprendendo meglio il meccanismo, speriamo di rendere questi trattamenti più efficaci».

UN IMPIANTO BIOINGEGNERIZZATO PER RIGENERARE LA RETINA
MOSTRA RISULTATI PROMETTENTI: PER LA PRIMA
VOLTA SI INTRAVEDE UN RECUPERO VISIVO
Perdere gradualmente la capacità di leggere, riconoscere i volti, mettere a fuoco un oggetto. È questa la traiettoria silenziosa, ma inesorabile, della degenerazione maculare senile, una patologia che colpisce milioni di persone nel mondo ed è oggi una delle principali cause di cecità negli anziani. Se per la forma umida della malattia esistono terapie farmacologiche in grado di rallentarne l’evoluzione, la variante più comune, la cosiddetta forma secca, è rimasta a lungo priva di cure efficaci. Ora, però, una nuova strategia terapeutica potrebbe cambiare questo scenario. Un gruppo di ricercatori della University of Southern California sta portando avanti uno studio clinico su un innovativo impianto bioingegnerizzato a base di cellule staminali, progettato per sostituire le cellule danneggiate della retina. Si tratta di un dispositivo ultrasottile, spesso appena pochi micron, che agisce come una sorta di cerotto biologico capace di riparare dall’interno uno dei tessuti più delicati dell’occhio umano. La degenerazione maculare colpisce la macula, una piccola ma fondamentale area al centro della retina responsabile della visione nitida e dettagliata. Con il progredire della malattia compaiono zone sfocate, macchie scure e veri e propri punti ciechi nel campo visivo centrale. Alla base di questo processo vi è il deterioramento dell’epitelio pigmentato retinico, uno strato di cellule che svolge un ruolo essenziale: nutre i fotorecettori, rimuove le sostanze di scarto e mantiene l’equilibrio metabolico della retina. Quando queste cellule muoiono o smettono di funzionare, i fotorecettori degenerano a loro volta. Nello stadio più avanzato, definito atrofia geografica, il danno diventa irreversibile e la perdita visiva severa.
È proprio per intervenire su questo meccanismo che è stato sviluppato l’impianto a cellule staminali. In laboratorio, cellule staminali embrionali vengono guidate a differenziarsi in cellule dell’epitelio pigmentato retinico. Queste vengono poi fatte crescere su un sottilissimo supporto biocompatibile, creando un foglietto cellulare organizzato e funzionale. Durante una procedura chirurgica mininvasiva, l’impianto viene inserito sotto la retina, nella zona danneggiata, con l’obiettivo di sostituire lo strato
cellulare perduto e ripristinare il supporto vitale ai fotorecettori ancora presenti. «Lo studio mira a capire se questo impianto ingegnerizzato riesca davvero a prendere il posto delle cellule danneggiate, a funzionare come un normale epitelio pigmentato retinico e, soprattutto, a migliorare la visione dei pazienti che oggi non hanno altre opzioni terapeutiche», ha spiegato Rodrigo Antonio Brant Fernandes, chirurgo oculista della Keck Medicine of USC e uno dei ricercatori coinvolti nella sperimentazione. I dati preliminari sono incoraggianti. In uno studio iniziale condotto su un numero limitato di pazienti, l’impianto si è dimostrato sicuro, stabile nel tempo e capace di integrarsi con il tessuto retinico circostante. Ma il risultato più rilevante riguarda la funzione visiva: circa il 27% dei partecipanti ha mostrato un miglioramento misurabile della vista, un dato significativo in una patologia tradizionalmente considerata senza possibilità di recupero. Sulla base di questi risultati è stato avviato uno studio clinico di fase 2b, che coinvolgerà pazienti tra i 55 e i 90 anni affetti da degenerazione maculare secca in stadio avanzato con atrofia geografica. L’obiettivo è ambizioso: dimostrare che l’impianto non solo rallenta la progressione della malattia, ma può produrre miglioramenti clinicamente significativi della visione e, in alcuni casi, invertire parte del danno già avvenuto.
Sebbene la strada verso un’applicazione clinica su larga scala sia ancora lunga, questo approccio rappresenta un cambio di paradigma. Non più solo farmaci per contenere la malattia, ma vere e proprie riparazioni cellulari, frutto dell’incontro tra medicina rigenerativa e ingegneria dei tessuti. Per i pazienti con degenerazione maculare secca, finora costretti ad assistere passivamente al declino della propria vista, il cerotto di staminali potrebbe trasformarsi, per la prima volta, in una concreta promessa di recupero visivo.
A rendere questa ricerca particolarmente rilevante è anche il suo valore simbolico per la medicina del futuro. La retina, infatti, è uno dei tessuti più complessi e sensibili dell’organismo, e riuscire a rigenerarne una parte funzionale rappresenta una sfida scientifica enorme. Il successo di questo impianto potrebbe aprire la strada a strategie simili per altre malattie neurodegenerative, dimostrando che la sostituzione mirata di cellule danneggiate non è più solo un’ipotesi teorica. In questo senso, il cerotto di staminali per la degenerazione maculare non è soltanto una possibile cura, ma un banco di prova per un nuovo modo di concepire la terapia rigenerativa. (C. P.).

Da gennaio gli Usa hanno promosso la decima edizione della piramide degli alimenti, con lo slogan “Rendiamo l’America di nuovo sana”
Il 7 gennaio scorso il governo statunitense ha rilasciato la nuova edizione delle “Linee Guida Nutrizionali per gli Americani”, valida fino al 2030. Questa pubblicazione ha causato molto movimento mediatico, a partire dalla copertina del documento, utilizzata anche dagli organi di stampa istituzionali del governo USA.
La copertina, infatti riporta l’immagine della “nuova piramide degli alimenti”, così chiamata proprio a livello istituzionale, per la quale si viene anche rimandati al sito ufficiale preposto, creato appositamente per il rilascio delle nuove linee guida: realfood.gov
Le prime linee guida in ambito dietetico vennero pubblicate negli USA nel 1977 ed erano materiale informativo creato appositamente per la popolazione americana dal comitato per la nutrizione del Senato statunitense. Già da allora veniva riconosciuto che le abitudini nutrizionali dei cittadini erano un problema di salute pubblica cruciale.
Nel 1979 il Surgeon General, cioè il medico che funge sostanzialmente da portavoce per tutta la sanità negli USA, rilascia un report per la promozione della salute e la prevenzione delle malattie, sostanzialmente la prima agenda sulla salute pubblica per la popolazione degli Stati Uniti, nel quale si prendono in considerazione anche la nutrizione e lo stile di vita come fattori fondamentali per ogni classe d’età per il raggiungimento degli obiettivi di salute pubblica che il report pone.
Dal 1980, anno della prima pubblicazione delle Linee Guida nutrizionali, ogni 5 anni, il governo ne ha rilasciato una nuova edizione. Dal 1992 si è utilizzata ufficialmente la Piramide dei cibi come icona delle Linee Guida, aggiornandola. Nel 2011 la Piramide viene sostituita da MyPlate, una grafica con un piatto diviso in settori che può assomigliare al Piatto Sano di Harvard, ma che presenta diverse differenze non banali da esso ( link ).
2026 - viene rilasciata la decima edizione e la piramide torna l’icona ufficiale. Ciò che ha scatenato l’hype sui social è proprio la piramide rovesciata usata sulla copertina del documento (*). Leggendo le otto pagine delle nuove linee guida nutrizionali per gli americani ciò che si nota è come, in realtà, non si discostino così tanto nei principi da quelle italiane. Il primo messaggio, evidenziato, del documento cita: “mangia cibo vero”, cioè, poco manipolato. Nella parte delle linee guida vere e proprie si evidenzia l’importanza di dare priorità a cereali integrali invece che a quelli raffinati, di mangiare sufficienti porzioni di verdura e di frutta, di non dimenticare le fonti proteiche magre e di alta qualità, nonché quelle vegetali, i derivati del latte fermentati, Viene anche riportato che è necessario mangiare secondo il proprio fabbisogno. Viene indicato di ridurre, se non eliminare, gli
* Comitato Centrale FNOB e delegata alla nutrizione

zuccheri aggiunti e gli alcolici e di prestare attenzione al consumo di sodio.
Le indicazioni per le popolazioni speciali (infanzia, adolescenza, gravidanza, allattamento, età avanzata, vegetarianismo e veganesimo) non si discostano dalle raccomandazioni oramai universalmente accolte. Pertanto, in merito ai principi generali, le nuove linee guida per gli americani non si discostano di molto da quelle italiane e da ciò che emerge in letteratura come abitudine nutrizionale protettiva. È invece molto interessante notare quanto queste nuove linee guida nutrizionali siano utilizzate per veicolare un messaggio politico.
La lettera di presentazione cita il famoso slogan “Make America Great Again” già nella prima riga: “Make America Healthy Again” (Rendiamo l’America di nuovo sana) è l’obiettivo esplicitato dal Segretario della salute e dei servizi umani e dal Segretario del Dipartimento dell’Agricoltura, che la firmano.
Sempre nella lettera di presentazione, si insiste sul valore del cibo come promotore della salute, come carburante per il movimento, l’energia e la forza. E si dichiara apertamente che con quel documento ci si sta riappropriando della rappresentazione a piramide, dei principi scientifici alla base della rappresentazione e del suo ruolo di divulgazione alla nazione tutta. I cittadini statunitensi sono, inoltre, sempre appellati come “Americani” per tutto il documento
Un messaggio, quindi, che aderisce completamente alla linea comunicativa dell’attuale amministrazione (America invece di Stati Uniti, Make America Great/Healthy Again) e che mette anche la nutrizione al servizio della narrazione corrente, fornendo ai cittadini uno strumento pratico e di facile comprensione per sostenere la salute nazionale tramite le scelte personali.

© renderis studio/shutterstock.com
La pelle è continuamente esposta a radiazioni UV, necessarie per la produzione di vitamina D3, ma un’eccessiva esposizione può provocare problemi, tra cui eritemi e persino cancro alla pelle. Ciò che aumenta il rischio di cancro della pelle sono le scottature solari e l'uso di creme con SPF adeguati è una misura preventiva importante, ma comunque tra gli ingredienti ce ne possono essere alcuni dannosi per la salute e l'ambiente.
La sicurezza dei filtri UV è sempre stata oggetto di studio, essendo la loro fotodegradazione in grado di generare sostanze tossiche, capaci di causare irritazioni o reazioni allergiche. Infatti, già nel 2019 la FDA ha diviso i principi attivi delle protezioni solari in tre categorie, vietandone l’utilizzo di alcuni, perché non sicuri per l’uomo e per l’ambiente. L’utilizzo di ingredienti naturali (es. oli vegetali) nelle creme solari aumenta sempre di più, questi infatti offrono proprietà emollienti e proteggono dai raggi UV.
Ciò che influenza la scelta di un prodotto piuttosto che un altro sono: proprietà estetiche, e misurazioni reologiche che forniscono informazioni sulle caratteristiche del prodotto. Si è visto che, l’olio di sesamo possiede una forte attività antiossidante e una resistenza ai raggi UV di circa il 30%, con un fattore di protezione solare (SPF) stimato di circa 2.
A seguire ci sono: oli di cocco, arachidi, oliva e semi di cotone, che presentano una resistenza alle radiazioni UV di circa il 20%, mentre l’olio d’oliva in letteratura ha uno dei valori SPF (circa 7,5-8) più elevati tra gli oli vegetali.
In uno studio di emulsioni stabili di acqua in olio, contenenti diversi oli vegetali, si è visto come questi influenzano le loro proprietà reologiche e il potenziale di protezione solare. Sono state create dieci formulazioni utilizzando cinque oli vegetali (olio d'oliva, olio di avocado, olio di sesamo, olio di semi di lino e olio di semi d'uva) a concentrazioni del 15% e 30%, più una formulazione di controllo senza olio, successivamente miscelate, raffreddate e conservate in contenitori di vetro. Le proprietà reologiche sono state misurate utilizzando un reometro, osservando il flusso e la viscosità

apparente. I test occlusivi in vitro hanno valutato la perdita d'acqua, un valore vicino a 0 indica nessun effetto occlusivo, mentre un valore vicino a 100 indica massima occlusione.
La protezione dai raggi UV è stata analizzata con uno spettrofotometro, calcolando i valori SPF. La stabilità delle formulazioni è stata testata attraverso centrifugazione e cicli di temperatura, ma dopo 30 giorni hanno mostrato una leggera diminuzione della viscosità. Dall’ analisi reologica è emerso che le proprietà delle emulsioni dipendono dalla viscosità degli oli e da fattori microstrutturali, l'aumento della concentrazione di olio influisce sulla struttura interna delle emulsioni in modo non lineare.
Quella col 30% di olio d'oliva è risultata essere la formulazione più occlusiva.
Dallo studio è emersa:
1. l'importanza degli oli vegetali nei prodotti solari, per la loro accessibilità e anche per i benefici che riguardano la salute, infatti c’è una crescente attenzione per l'estetica e le prestazioni di questi prodotti, i consumatori li preferiscono perché non sono grassi ma offrono comunque protezione dall'acqua; 2. la composizione degli oli vegetali influisce sull'estetica e sull'efficacia idratante;
3. le emulsioni W/O sono state formulate con successo, mostrando un miglioramento dell'SPF e suggerendo di combinare oli vegetali con filtri UV approvati.
Bibliografia
* Comitato Centrale FNOB
rare

L'aferesi terapeutica è una procedura medica che filtra selettivamente il sangue per rimuovere componenti dannose (come anticorpi, lipoproteine, cellule anomale) e trattare malattie rare che non rispondono ad altre terapie, includendo disturbi neurologici (neuromielite ottica, Guillain-Barré), reumatologici (lupus), ematologici (anemia falciforme, ipercolesterolemia familiare, porpora trombotica trombocitopenica) e condizioni legate a eccessiva viscosità del sangue, offrendo una soluzione vitale per patologie croniche e acute, spesso in combinazione con immunosoppressori.
L’uso dell’aferesi segue le linee guida internazionali della American Society for Apheresis (ASFA), aggiornate periodicamente (ultima edizione rilevante 2023, con nuovi aggiornamenti previsti nel ciclo triennale fino al 2026.
Le patologie sono divise in tre categorie: categoria I (terapia di prima linea, i.e. PTT, Guillain-Barrè); categoria II (terapia di seconda linea o di supporto); categoria III (ruolo non ancora stabilito, decisione caso per caso).
Definizione e tipi di trattamento aferetico attualmente praticabili
L’aferesi terapeutica è un trattamento che separa il sangue in vari componenti (pla -
* Responsabile Ufficio Aziendale Malattie Rare, Azienda USL Toscana Nord Ovest
sma, globuli rossi, piastrine) usando macchine chiamate separatori cellulari, rimuovendo o sostituendo le parti patologiche e reinfondendo quelle sane al paziente.
I tipi di trattamenti possibili sono: plasma-exchange o PEX (sostituzione del plasma); aferesi per filtrazione (o doppia filtrazione) a cascata (tecnica avanzata di aferesi terapeutica che utilizza due filtri a membrana in serie per separare selettivamente dal plasma del paziente macromolecole, immunocomplessi e altre sostanze dannose come LDL, Lp(a), fibrinogeno, trattenendole nel filtro secondario, mentre plasma, globuli rossi e piastrine vengono restituiti al paziente, offrendo un'alternativa mirata alla plasmaferesi tradizionale per patologie metaboliche e autoimmuni); leucaferesi/piastrinoaferesi citoriduttiva/ eritroaferesi depletiva (riduzione/rimozione di cellule specifiche, i.e. leucociti, globuli rossi malati, etc.); scambio eritrocitario o eritro-exchange o eritroaferesi (sostituzione dei globuli rossi danneggiati con quelli sani).
Effetti indesiderati
Gli effetti indesiderati sono molto rari, soprattutto quelli di maggior rilievo clinico. Possono verificarsi: ematomi o piccoli stravasi intorno agli accessi venosi con risoluzione spontanea in pochi giorni; in corso di procedura: formicolii, prevalentemente intorno alle labbra, brividi, nausea e crampi muscolari.
Trattasi di effetti indesiderati, dovuti
all'anticoagulante (ACD-A), che rispondono in breve tempo all'infusione di calcio gluconato in vena; effetti indesiderati più rari: reazioni allergiche (al liquido sostitutivo), ipotensione arteriosa persistente, alterazione del ritmo cardiaco, embolia, emolisi. Qualora il liquido sostitutivo impiegato sia un emoderivato, vanno annoverati i rischi ad esso connessi.
Controindicazioni assolute alla terapia afe retica
Condizioni di grave insufficienza cardiocircolatoria o respiratoria possono rappresentare una controindicazione a qualsiasi trattamento di circolazione extracorporea, come l’aferesi terapeutica. In presenza di queste condizioni e, stante la necessità assoluta di effettuare il trattamento per il tipo d’indicazione, questo verrà condotto presso le Unità di Terapia Intensiva, onde garantire il costante monitoraggio di tutte le funzioni vitali e quindi la sicurezza del paziente.
Malattie rare trattate
• Neurologiche: neuromielite ottica, sindrome di Guillain-Barré, miastenia grave, sclerosi multipla (in fase acuta).
• Ematologiche: porpora trombotica trombocitopenica, anemia falciforme (per rimuovere cellule malate), leucemie, crisi emolitiche.
• Reumatologiche: lupus eritematoso sistemico (per eliminare autoanticorpi).
• Cardiovascolari: ipercolesterolemia familiare (FH) e altre dislipidemie gravi, tramite aferesi delle lipoproteine (LDL-aferesi).
• Altre: malattie che richiedono riduzione della viscosità del sangue (reoferesi) o trattamento della malattia da trapianto (GVHD).
Perchè è importante per le malattie rare
Molte di queste patologie hanno un'incidenza bassa e sono croniche, e l'aferesi può essere cruciale quando i farmaci tradizionali falliscono, sebbene spesso sia parte di un approccio terapeutico più ampio (es. con immunosoppressori) per prevenire ricadute.
Diritti e agevolazioni in Italia al 2026
In conformità con il D.M. 279/2001, i pa -

zienti con diagnosi di malattia rara hanno diritto all'esenzione per tutte le prestazioni appropriate ed efficaci, inclusa l'aferesi terapeutica se indicata. Per il 2026 sono attivi bandi specifici per la ricerca sulle malattie rare per migliorare l'efficacia delle terapie aferetiche e facilitare il drug repurposing.
Fonti/Riferimenti Biologi:
• Osservatorio Malattie Rare
• Iss
• Ammtac

di Gianpaolo Palazzo

RICERCA
ENEA – UNIVERSITÀ
DI SALERNO: USARE I CAMPI
ELETTRICI PULSATI ABBATTE
I CONSUMI TERMICI DEL 60%.
QUALITÀ INTATTA, COSTI OPERATIVI
GIÙ E MENO DIPENDENZA DAL GAS PER L’INDUSTRIA
Nelle viscere di uno stabilimento che lavora succo d’arancia, il profumo di agrumi convive con un rumore costante: quello dell’energia che entra in caldaie, scambiatori, tubazioni. Per rendere sicuro un liquido “vivo” come la frutta, l’industria da decenni ripete lo stesso copione: scalda e raffredda, rapidamente, moltissimo. È efficace, ma costa. Oggi, mentre gas ed elettricità pesano più che mai sui bilanci, una ricerca di Enea, in collaborazione con il Dipartimento d’ingegneria industriale dell’Università degli Studi di Salerno e pubblicata sulla rivista “Foods” (https://doi.org/10.3390/foods14132239), indica un cambio di regia: affiancare ai metodi termici una tecnologia basata sui campi elettrici pulsati, PEF (Pulsed electric fields), integrata con recupero di calore dalla pastorizzazione. I risultati, ottenuti su un caso studio industriale di medie dimensioni che tratta 16,5 milioni di litri di succo d’arancia all’anno, suggeriscono un potenziale taglio dei consumi del 20% per la componente elettrica e del 60% per quella termica, rispetto alla pastorizzazione tradizionale HTST (High temperature short time), il processo ad alta temperatura e breve durata usato come riferimento.
Lo studio mette alla prova diverse combinazioni operative considerando vari livelli di efficienza nel recupero del calore e tre temperature di preriscaldamento del succo prima del trattamento PEF (35 °C, 45 °C e 55 °C), con l’obiettivo di misurare consumi energetici, sostenibilità economica e impatto ambientale. Il

funzionamento spiega perché la promessa è credibile: il succo viene esposto a impulsi elettrici di brevissima durata ed elevata intensità che danneggiano le membrane cellulari di lieviti e batteri patogeni, riducendo in modo significativo la carica microbica; al tempo stesso, la minore “aggressività” termica aiuta a preservare qualità, valore nutrizionale, sapore e colore fino a tre settimane, e la tecnologia può essere integrata nelle linee produttive esistenti. La spinta, però, non è solo tecnologica: è energetica, industriale, strategica: «L’adozione di tecnologie più efficienti e sostenibili è fondamentale per ridurre consumi energetici e dipendenza dal gas dell’industria alimentare», spiega Giovanni Landi, ricercatore del Laboratorio Enea Soluzioni integrate per l’efficienza energetica e coautore dello studio insieme ai colleghi Miriam Benedetti e Matteo Sforzini e ai ricercatori Gianpiero Pataro ed Elham Eslami dell’Università di Salerno. Aggiunge, chiarendo quale assetto risulti
più vantaggioso: «Le tecnologie non termiche, come i campi elettrici pulsati possono rappresentare un’interessante alternativa o una possibile integrazione ai metodi termici tradizionali per la conservazione degli alimenti liquidi. La configurazione più efficiente, sia dal punto di vista energetico che ambientale, prevede il recupero del 35% del calore di scarto dal succo pastorizzato, che viene utilizzato per preriscaldare a 55 °C nuovo succo fresco». È qui che l’innovazione “chiude il cerchio”: parte dell’energia che oggi si disperde viene recuperata e riutilizzata per preparare il prodotto in ingresso, riducendo il fabbisogno complessivo. Resta il principale freno all’adozione nel settore bevande: l’investimento iniziale, stimato in circa 680mila euro per la tecnologia PEF contro i 200mila euro necessari per la soluzione oggi più utilizzata. Ma lo studio mostra perché molte imprese potrebbero guardare oltre la barriera d’ingresso, concentrandosi sui costi operativi. «L’adozione industriale


del processo PEF, soprattutto se combinato a un riscaldamento moderato, rappresenta un sistema chiave per il risparmio energetico, in alternativa ai metodi termici ad alto consumo di energia. Abbiamo stimato che il costo unitario di pastorizzazione con il trattamento PEF si attesta a 3,5 centesimi al litro, rispetto ai 4,2 centesimi al litro del processo termico tradizionale», conclude Landi.
Sul piano ambientale, nella configurazione più efficiente, il confronto con l’HTST convenzionale per il succo d’arancia (90 °C per 15 secondi, con uno stadio di recupero del calore) indica una riduzione delle emissioni di gas serra di circa il 30% e del consumo idrico del 25%. Numeri che pesano in un comparto in cui i processi termici energivori - pastorizzazione, sterilizzazione, essiccazione e cottura - rappresentano tra il 20% e il 50% dei consumi, con emissioni di CO2 e impronta idrica pari rispettivamente al 3,6% e 4,4% del totale mondiale.
La ricerca è stata finanziata da Enea
nell’ambito del Programma di Ricerca di Sistema Elettrico (Piano Triennale di Realizzazione 2022-2024), Progetto 1.6 con l’Università di Salerno co-beneficiaria di una specifica attività nel Work package dedicato all’efficienza e all’ottimizzazione dei processi, dei distretti e delle filiere industriali. Sullo sfondo, però, resta la cornice regolatoria: l’adozione della tecnologia nella trasformazione alimentare deve confrontarsi con normative e standard differenti in materia di sicurezza alimentare e valutazione del rischio. Anche l’etichettatura incide: nei principali mercati, Unione Europea e Stati Uniti, non esistono obblighi specifici per gli alimenti trattati con PEF. È un intreccio di scienza, impianti e regole, ma il punto resta netto: se l’industria dei succhi vuole alleggerire davvero bollette, emissioni e dipendenza dal gas senza rinunciare alla qualità, la strada indicata non passa solo da caldaie più efficienti, ma da una “scossa” controllata e da un recupero intelligente del calore.

LA RICERCA NEL PROGETTO UE HORIZON
2020 ISOLA LA FRAZIONE PLASTICA NEL PM10
E C’È UN PARADOSSO ECOLOGICO: I VEICOLI
A ZERO EMISSIONI RILASCIANO COMUNQUE PARTICELLE NOCIVE
C’è una polvere fantasma che si solleva a ogni semaforo rosso, spunta una nebbia secca, impercettibile e accompagna la frenata improvvisa o la ripartenza nervosa nel cuore delle metropoli. Non la vedete uscire dai tubi di scappamento, non possiede l’odore acre e pungente della benzina incombusta che per decenni ha stigmatizzato il progresso industriale, eppure satura l’aria urbana con una persistenza insidiosa. È l’inquinamento generato dall’attrito puro, dalla fisica “brutale” dei materiali, che si consumano sull’asfalto millimetro dopo millimetro.
Le concentrazioni inquinanti derivate dall’usura degli pneumatici possono risultare fino a cinque volte più elevate nelle zone urbane caratterizzate da traffico intenso, rispetto alle aree più verdi. L’amara verità emerge da uno studio internazionale pubblicato sulla rivista scientifica “Atmospheric Environment” (https://doi.org/10.1016/j.atmosenv.2025.121257) e condotto nell’ambito del progetto europeo Polyrisk, finanziato dal programma Horizon 2020 con il contributo determinante dell’Enea. Non è un semplice monitoraggio statistico, ma parte integrante di una più vasta e ambiziosa attività di ricerca che punta a valutare con precisione gli effetti dell’esposizione alle micro e nano plastiche sulla salute umana, accendendo un faro su una minaccia ambientale spesso sottovalutata rispetto alle più note emissioni gassose.
La narrativa ecologica si è concentrata per anni sul motore, dimenticando le ruote. «In città una delle principali fonti di inquinamento da microplastiche è rappresentata dalle minuscole particelle generate dall’attrito degli pneumatici sull’asfalto durante la normale circolazione dei veicoli. Finora, solo pochi studi internazionali hanno quantificato le concentrazioni atmosferiche di queste particelle», spiega Maria Rita Montereali, ricercatrice del laboratorio Enea “Impatti sul territorio e nei Paesi in via di sviluppo” e coautrice dello studio insieme alle colleghe Laura Caiazzo e Sonia Manzo. «Con il nostro lavoro - aggiunge - abbiamo voluto misurare la presenza di queste microplastiche e valutarne le variazioni in relazione ad altri inquinanti primari, analizzando aree con differenti condizioni di circolazione.
I dati raccolti potranno essere utilizzati per verificare le possibili associazioni con gli effetti sulla salute». Per comprendere la reale e spaventosa portata del fenomeno, il team ha trasformato la città di Utrecht, nei Paesi Bassi, in un laboratorio a cielo aperto tra il 2022 e il 2023. La scelta non è casuale: si stima che solo lì vengano rilasciate nell’aria, ogni anno, tra le 880 e le 2900 tonnellate di particelle plastiche per l’abrasione della gomma su strada. Una quantità che finisce dritta nei nostri polmoni. I ricercatori hanno monitorato tre siti strategici: una strada urbana afflitta dal tipico andamento a singhiozzo (stop-and-go), un tratto autostradale con traffico elevato, ma scorrevole, e un parco cittadino, oasi verde distante cinquanta metri dalla strada secondaria più vicina.
Le campagne di campionamento, durate quattro ore giornaliere per ventitré giorni, hanno catturato una fotografia dettagliata dell’aria che respiriamo. Per distinguere la gomma dal resto del pulviscolo urbano (PM10), gli scienziati hanno agito come investigatori forensi, utilizzando marcatori chimici specifici di gomma sintetica e naturale e un tracciante per il benzotiazolo, additivo fondamentale per indurire la mescola (considerato anch’esso un marcatore di particolare interesse, perché impiegato nei test di tossicità in vitro e in vivo). In parallelo, sono stati rilevati i metalli come ferro, rame, cromo e manganese, figli dell’usura legata ai freni.
Nel parco, la quiete si riflette sui numeri: concentrazioni di microplastiche minime, tra 3,1 e 5,1 nanogrammi per metro cubo. Avvicinandosi all’autostrada, dove la velocità è costante, i valori salgono tra 7,8 e 18,1 (ng/m³). L’epicentro del problema, tuttavia, si registra nella zona a traffico intermittente: rispetto al parco, i livelli di gomma nell’aria erano fino a tre volte più alti in autostrada, ma quasi cinque volte maggiori dove le auto frenano e ripartono con frequenza. Anche il benzotiazolo segue questa curva preoccupante: 2,4 volte superiore in autostrada e ben 4,6 volte maggiore nel traffico urbano discontinuo. Nei campioni raccolti, la quantità di microplastiche da pneumatici rappresentava in media lo 0,45% del particolato PM10 (valori compresi tra 0,07% e 1,48%): una frazione abbastanza piccola, il cui peso potrebbe prossimamente aumentare. Siamo, infatti, di fronte a un paradosso tecnologico imminente. «La diffusione dei veicoli elettrici - conclude Sonia Manzo, che ha coordinato lo studio - ridurrà in parte le emissioni di inquinanti legati alla combustione, ma è prevedibile che comporterà un aumento dei livelli di microplastiche prodotte dall’usura e dal contatto con l’asfalto degli pneumatici, a causa di un attrito superiore per il maggior peso di tali veicoli». Il futuro della mobilità sostenibile dovrà fare i conti con questa nuova, “pesante” variabile: abbiamo eliminato il fumo nero visibile, ma ora dobbiamo occuparci della polvere grigia, quella che non si vede, ma racconta il peso reale del nostro muoverci nel mondo. (G. P.).

Dimentichiamoci le cattedrali nel deserto: il 70% dei siti è piccolo, sono ex officine o depositi nel tessuto urbano Una sfida capillare che tocca ben 3.619 municipi

© Stokkete/shutterstock.com

© Andy Soloman/shutterstock.com
Esiste una cartografia invisibile che si sovrappone a quella delle città d’arte e dei paesaggi da cartolina, una geografia delle cicatrici: non compare sulle guide turistiche, ma racconta la profonda eredità industriale del Paese. È la mappa disegnata dal IV Rapporto sulle bonifiche dei siti regionali pubblicato dall’Ispra, un documento che, attraverso il rigore dei numeri, scatta una fotografia nitida dello stato di salute del suolo nazionale.
Al primo gennaio 2024, quasi la metà dei Comuni italiani - per l’esattezza il 46%, pari a 3.619 amministrazioni - si trova a dover gestire almeno un iter legato a potenziali contaminazioni. Non è un fenomeno di nicchia, né una questione relegata a poche aree dismesse, ma una realtà che tocca quasi un municipio su due, ridisegnando la percezione dell’inquinamento non come eccezione tragica, bensì come questione amministrativa quotidiana. Il dossier, basato sui dati trasmessi dal Sistema nazionale per la protezione dell’ambiente e dalle Regioni per alimentare Mosaico, la banca dati nazionale, censisce una mole impressionante di fascicoli: 16.365 pratiche in corso e 22.191 ormai archiviate. Queste cifre, tuttavia, vanno decifrate con competenza per evitare facili allarmismi. Il dato più rilevante che emerge dall’analisi costituisce, infatti, un potente antidoto alla paura indiscriminata: l’apertura di un fascicolo non equivale a una sentenza di condanna per il territorio. Al contrario, il sistema funziona come un filtro efficace,
AL PRIMO GENNAIO 2024, QUASI LA METÀ DEI COMUNI ITALIANIPER L’ESATTEZZA IL 46%, PARI A 3.619 AMMINISTRAZIONI - SI TROVA A DOVER GESTIRE
ALMENO UN ITER LEGATO A POTENZIALI CONTAMINAZIONI
capace di distinguere il sospetto dalla realtà, tanto che il 70% dei procedimenti regionali si è concluso senza la necessità di alcun intervento di bonifica.
Significa che, nella stragrande maggioranza dei casi, le indagini preliminari hanno escluso rischi per la salute e l’ambiente, permettendo di chiudere la pratica senza muovere terra; solo nel restante 30% l’allarme si è rivelato fondato, rendendo necessario attivare le tecnologie di risanamento. Questo ci restituisce l’immagine di un’Italia che controlla e verifica, ma che non può abbassare la guardia: ogni anno la macchina amministrativa registra l’apertura di circa 1.190 nuovi fascicoli, un flusso costante, testimonianza di una pressione antropica che non accenna a diminuire. Scendendo nel dettaglio operativo, sono censiti 3.243 procedimenti, i quali hanno superato la fase d’indagine e si trovano nel vivo dell’intervento: di questi, 2.601 sono cantieri aperti, ferite in via di cicatrizzazione, mentre per altri 642 i lavori sono tecnicamente terminati in attesa della certificazione finale.
La loro geografia non è omogenea, ma ricalca fedelmente le direttrici dello sviluppo economico del Novecento: non stupisce che la Lombardia concentri il 28% dei procedimenti in fase di intervento, seguita dal Piemonte con il 12% e dalla Toscana con l’11%. È il conto presentato dalla storia a regioni che hanno trainato l’economia e oggi si fanno carico del risanamento. Un capitolo del Rapporto merita un’attenzione particolare perché tocca la
© JU.STOCKER/shutterstock.com


©
giustizia ambientale: quello dei “siti orfani”, aree contaminate dove il principio «chi inquina paga» si è infranto contro la realtà, perché il responsabile non c’è più, è fallito o non ha risorse. A Capodanno di due anni fa l’Italia contava 484 di questi fantasmi ecologici, per lo più eredità di un’epoca in cui la sensibilità ambientale era nulla. La novità positiva è che la macchina pubblica si è messa in moto grazie alle risorse del Pnrr: dei 484 siti orfani, 225 hanno ottenuto finanziamenti e per 55 l’iter si è concluso. Un altro mito che i dati dell’Ispra sfatano è quello che immagina le bonifiche come operazioni riguardanti solo giganteschi poli petrolchimici. La realtà è molto più parcellizzata e quotidiana: il 70% delle aree interessate è inferiore ai 10mila metri quadrati, e il 30% non raggiunge i mille. Parliamo spesso di ex distributori, piccole officine, depositi artigianali, ovvero il tessuto della piccola impresa italiana; solo nel 18% dei casi ci troviamo di fronte a superfici superiori ai 20 ettari, confermando che la contaminazione è un fenomeno di prossimità, vive, purtroppo, accanto alle nostre case.
Infine, la variabile tempo, nemico giurato della salute pubblica. Quanto ci vuole per bonificare? La percezione comune suggerisce tempi biblici, ma i dati offrono una lettura più sfumata: la metà dei procedimenti che arrivano a conclusione con un intervento termina il proprio “viaggio” in meno di quattro anni, un lasso di tempo che, considerate le complessità tecniche e burocratiche, può essere considerato fisiologico. Esiste tuttavia uno “zoccolo duro” di procedimenti complessi, quel 25% di casi dove sono necessari almeno otto anni per vedere la fine del tunnel: sono i siti più compromessi, dove l’inquinamento è penetrato nelle matrici profonde o dove le battaglie legali hanno rallentato le ruspe. Questo IV Rapporto a non è solo una collezione di statistiche, ma uno strumento di navigazione essenziale che dimostra come il sistema di monitoraggio diventi sempre più preciso. In un Paese che ha fame di spazi e sete di sicurezza, la bonifica non è solo un atto tecnico dovuto, ma una forma alta di cura del bene comune, un risarcimento necessario che trasforma i vuoti urbani in nuove opportunità di vita. (G. P.).
UNO STUDIO ITALIANO
SVELA COME SINGOLE CELLULE
VEGETALI PERCEPISCONO
L’IPOSSIA E RIMODULANO CRESCITA
E METABOLISMO PER
SOPRAVVIVERE ALLO STRESS
CLIMATICO
Le piante non hanno polmoni, eppure respirano anche loro. Ogni cellula vegetale ha bisogno di ossigeno per ricavare energia dai nutrienti e sostenere processi vitali come crescita, divisione cellulare e risposta allo stress. Ma cosa succede quando l’ossigeno viene a mancare? È una situazione tutt’altro che rara in natura, soprattutto nelle radici, dove la disponibilità di aria dipende dalla struttura del terreno e dalla presenza di acqua. Proprio per capire come le piante affrontano questa condizione detta ipossia, un gruppo di ricerca italiano ha individuato un tassello fondamentale: l’arma è nei geni, capaci di percepire la scarsità di ossigeno e di rimodulare la crescita per aumentare le probabilità di sopravvivenza.
A descrivere questo meccanismo è uno studio guidato dalla Scuola Superiore Sant’Anna di Pisa, pubblicato sulla rivista npj Science of Plants, con la collaborazione della Scuola Normale Superiore e dell’Istituto di Biologia e Biotecnologia Agraria del Cnr di Pisa. Il lavoro si inserisce nel quadro delle sfide poste dal cambiamento climatico: eventi meteorologici estremi, piogge improvvise e allagamenti sempre più frequenti rendono urgente sviluppare colture in grado di resistere a condizioni limite, come suoli saturi d’acqua o poco aerati. Il punto di partenza è un dato biologico spesso sottovalutato: molte parti della pianta vivono già, per natura, in un ambiente povero di ossigeno. Le radici, per esempio, possono trovarsi in microzone in cui l’aria fatica




DALL’ANALISI È EMERSA
L’ESISTENZA DI GENI SENSIBILI ALLA DISPONIBILITÀ DI OSSIGENO: UNA SORTA DI SENSORI E REGOLATORI CHE
TRADUCONO UN SEGNALE
AMBIENTALE (L’ARIA CHE MANCA) IN UNA RISPOSTA BIOLOGICA COORDINATA
a diffondersi; inoltre, nei tessuti più interni, l’ossigeno può diminuire per il semplice fatto che deve attraversare diversi strati cellulari prima di arrivare a destinazione. In queste condizioni le cellule devono scegliere: continuare a crescere come se nulla fosse (rischiando il collasso energetico) oppure rallentare, cambiare strategia metabolica, investire in percorsi alternativi. La novità dello studio sta nel metodo: anziché analizzare le risposte genetiche in media su un intero tessuto, i ricercatori hanno osservato ciò che avviene a livello di singola cellula. È un cambio di prospettiva decisivo, perché una radice non è un blocco uniforme: è un mosaico di cellule con ruoli differenti, che possono reagire in modo diverso allo stesso stress. Guardare il comportamento genico cellula per cellula permette di individuare con precisione quali programmi molecolari si accendono e quali si spengono, e soprattutto dove avviene questo interruttore.
Dall’analisi è emersa l’esistenza di geni particolarmente sensibili alla
disponibilità di ossigeno: una sorta di sensori e regolatori che traducono un segnale ambientale (l’aria che manca) in una risposta biologica coordinata. Alcune cellule attivano geni che riorientano il metabolismo verso vie meno dipendenti dall’ossigeno; altre modulano la crescita, rallentandola o rimodellandola. Questo adattamento, nato nel microcosmo cellulare, si riflette poi sul comportamento dell’intera pianta: può significare, per esempio, un diverso sviluppo radicale o una gestione più prudente delle risorse durante lo stress.
«Grazie a questo studio possiamo osservare come le piante reagiscono alle variazioni di ossigeno a livello di singola cellula», commenta Paolo Maria Triozzi, tra i coordinatori della ricerca, «aprendo la strada all’identificazione di geni chiave che guidano la crescita in base alla disponibilità dell’ossigeno». In altre parole, la risposta non è solo resistere: è decidere come crescere quando l’ambiente diventa ostile. Le implicazioni applicative
sono importanti. Se si identificano i geni che rendono più efficiente questa risposta, si possono selezionare o sviluppare varietà agricole più robuste: piante capaci di tollerare meglio gli allagamenti temporanei, di crescere in suoli compatti o poveri d’aria, di mantenere una produttività accettabile anche quando le condizioni non sono ideali. È un obiettivo cruciale per la sicurezza alimentare, perché molti dei terreni agricoli più produttivi sono anche quelli più esposti a fenomeni di ristagno idrico e stress radicale.
In un futuro in cui l’agricoltura dovrà fare i conti con l’instabilità climatica, la ricerca di base diventa una leva concreta di resilienza. E questa storia lo dimostra bene: nel silenzio delle radici, in un ambiente dove l’ossigeno a volte non basta, le piante hanno già un piano. È scritto nei loro geni. La sfida ora è tradurre questi risultati in strumenti per il miglioramento genetico. Perché capire come una pianta ‘misura’ l’ossigeno significa renderla pronta a un clima che cambia.


DAI PARCHI AI LITORALI
IL CONSUMO MORDI E FUGGI
LASCIA TRACCE VISIBILI: PRODOTTI
PICCOLI E LEGGERI SFUGGONO
AI CESTINI E RESTANO SOTTO GLI
OCCHI DI TUTTI, IN OGNI STAGIONE
Quarantamila. Non è il pubblico di uno stadio, né il numero di abitanti di una cittadina di provincia. È il censimento dell’abbandono: oltre qua rantamila rifiuti raccolti, catalogati, contati uno per uno in tre anni di monitoraggio lungo la Penisola. Dieci parchi, dieci spiagge, venti luoghi che dovrebbero rappresentare il meglio del patrimonio naturale italiano e che, invece, restituiscono l’immagine di un Paese in affanno nella gestione dei propri scarti. Il report di Legambiente “Beach e Park Litter” ci dà un unico, impietoso verdetto: l’Italia è sommersa dalla plastica, e la plastica non perdona. I dati tracciano una geografia dell’incuria che va da Nord a Sud, dalle aree verdi urbane fino alle coste più frequentate dai bagnanti. L’80% di quegli oggetti abbandonati è costituito da materiali plastici, prevalentemente monouso: tappi, buste, bottiglie, bicchieri. Articoli progettati per durare pochi minuti nelle nostre mani e destinati a persistere per secoli negli ecosistemi, frammentandosi in microplastiche che contaminano suoli, falde acquifere e catene alimentari.
Ogni pezzo diventa una bomba a orologeria, un veleno silenzioso che entra nel ciclo della vita e non ne esce più. Il restante 20% degli scarti rinvenuti si distribuisce in una costellazione di materiali che compone il ritratto fedele delle nostre abitudini quotidiane: metalli al 6,8%, principalmente lattine e tappi o capsule; carta e cartone al 5,9%, spesso confezioni alimentari destinate a disfarsi sotto le prime


piogge; vetro e ceramica al 3,6%, pericolosi per la fauna e per chi frequenta le aree naturali; gomma all’1,3%; tessuti 1,1%, frammenti di abbigliamento e accessori dimenticati o gettati; legno 0,5%; residui alimentari 0,3%; materiali misti 0,2%. Poi, in fondo alla classifica con un’identica percentuale dello 0,2%, le bioplastiche compostabili e biodegradabili. Proprio quest’ultimo dato merita una riflessione che ribalta alcune narrazioni consolidate nel dibattito europeo: appare marginale a prima vista, ma diventa eloquente se confrontato con le 82,2 chilotonnellate (kt) di questi materiali immesse sul mercato italiano.
In altre parole, mentre la plastica tradizionale domina nettamente i ritrovamenti, nell’indagine le bioplastiche risultano residuali. Quattro anni fa, quando l’Italia ottenne l’esenzione di tali prodotti dalla direttiva europea SUP (Single Use Plastic) sul monouso, le critiche arrivarono da Bruxelles e da altre capitali del continente: scelta incomprensibile, dissero; favore all’industria nazionale, insinuarono; deroga ingiustificata, attaccarono. I numeri di questa indagine triennale raccontano una storia diversa: le bioplastiche compostabili non sono diventate un problema ecologico e hanno, anzi, contribuito a ottimizzare la raccolta differenziata dell’organico senza trasformarsi in scarti che minacciano habitat e biodiversità. La nascita del consorzio dedicato apre ora la strada a sistemi di monitoraggio più raffinati e a politiche di prevenzione calibrate su evidenze verificabili, non su pregiudizi o timori generici. Se le bioplastiche superano l’esame dei fatti, i polimeri tradizionali restano, invece, un’emergenza che il recepimento della direttiva non ha saputo arginare.
Il decreto legislativo 196/2021, che avrebbe dovuto tradurre in pratica le ambizioni comunitarie di riduzione dell’usa e getta, non ha ancora prodotto gli effetti sperati: tappi e bicchieri a perdere continuano a invadere litorali e spazi verdi con percentuali che definire allarmanti è un eufemismo. Perché? Parte della risposta risiede in un vulnus normativo che indebolisce l’intero impianto: né la direttiva europea né il decreto italiano definiscono con precisione il concetto di “riutilizzabile”. Una lacuna apparentemente tecnica, ma dalle conseguenze concrete: spalanca le porte a interpretazioni elastiche da parte delle aziende, a manufatti formalmente conformi, ma, sostanzialmente, monouso, a un mercato che trova nuove vie per aggirare lo spirito delle norme mantenendo intatti i margini di profitto.
Ci troviamo, pertanto, davanti a una doppia sfida che richiede coraggio politico e visione strategica: applicare con rigore le disposizioni esistenti per ridurre drasticamente la plastica monouso e, allo stesso tempo, colmare con urgenza quel vuoto definitorio che consente a molti prodotti in polimeri convenzionali di sopravvivere sotto mentite spoglie, spacciati per riutilizzabili quando non lo sono. Non è accanimento ideologico contro un materiale:

è difesa della biodiversità, degli ecosistemi marini e terrestri, della qualità ambientale che definisce l’identità del Paese e sostiene anche la sua attrattività. Quei quarantamila scarti censiti sono schegge di un modello che trasferisce sull’Ambiente i costi della propria comodità, prove tangibili di un patto sociale incrinato tra cittadini e territorio. Il monitoraggio triennale ha fatto il proprio


© igra.design/shutterstock.com
lavoro: ha contato, classificato, documentato. Ora la parola passa alla politica, all’industria, a tutti noi che ogni giorno scegliamo che cosa acquistare e come smaltirlo. Perché quei numeri, se continueremo a ignorarli, non potranno che crescere e l’Italia non può permettersi di diventare la discarica a cielo aperto delle proprie cattive abitudini. (G. P.).

© saravutpics/shutterstock.com

Prevedere un’eruzione vulcanica è una delle sfide più complesse nell’ambito della geofisica: i vulcani non seguono degli schemi regolari, e i segnali precursori di un’eruzione sono spesso ambigui dal momento che ogni sistema magmatico ha un comportamento unico.
Proprio per queste ragioni, gli scienziati dell’Istituto Nazionale di Geofisica e Vulcanologia, insieme ai ricercatori dell’Università di Torino e di Cambridge, hanno sviluppato un nuovo modello predittivo che combina dati geofisici tradizionali agli algoritmi dell’intelligenza artificiale.
L’obiettivo è migliorare l’inter -
pretazione dei segnali che precedono un’eruzione, riducendo i falsi allarmi e i mancati avvisi. Il modello a seguito dell’analisi di migliaia di eventi come deformazioni del suolo, variazioni nella sismicità, emissioni di gas e cambiamenti nella temperatura superficiale registrati negli ultimi decenni. Questi parametri, già utilizzati nei sistemi di monitoraggio, vengono ora integrati da reti neurali capaci di riconoscere dei “pattern” che sfuggono all’analisi umana.
Secondo gli autori dello studio, pubblicato su Science Advances, l’IA non sostituisce il lavoro dei vulcanologi, ma potenzia la loro capacità di interpretare i segnali, spesso
Un sismografo integra IA e dati geofisici per prevedere le eruzioni con maggiore precisione e ridurre i falsi allarmi
complessi e contraddittori. Uno dei risultati più interessanti riguarda la possibilità di distinguere tra un’attività pre-eruttiva e le semplici fasi di agitazione interna del vulcano. Molti sistemi, come ad esempio quello dell’Etna o dei Campi Flegrei, mostrano periodi di intensa sismicità o di deformazione che non sfociano necessariamente in un’eruzione.
Il nuovo modello, fondato su casi reali, riesce a identificare le combinazioni di segnali che indicano una probabile risalita del magma verso la superficie. Questo approccio riduce il rischio di evacuazioni inutili, che sulle popolazioni che abitano nei pressi di vulcani attivi hanno un impatto sociale ed economico non indifferente, e allo stesso tempo aumenta la capacità di riconoscere precocemente situazioni realmente pericolose.
Il sistema è stato testato su diversi vulcani in attività, tra cui, per esempio, il Kīlauea alle Hawaii e il Nevado del Ruiz in Colombia, mostrando una certa versatilità di applicazione su altri sistemi.
Tuttavia, gli scienziati spiegano come ogni vulcano abbia una sua “personalità”, e che i modelli devono quindi essere adattati ai contesti locali. Proprio per queste ragioni, l’INGV sta lavorando alla creazione di archivi digitali sempre più completi, che includano dati storici e osservazioni satellitari ad alta risoluzione. L’integrazione tra IA e geofisica apre a una nuova fase nella gestione di questi eventi, che non consiste nella previsione certa del momento dell’eruzione, ma nel migliorare la comprensione delle probabilità che l’evento si verifichi o meno. Studi come questo sono fondamentali, inoltre, perché permettono di comprendere meglio il funzionamento del nostro pianeta e i processi che lo governano.
Le larve di Meloe proscarabeus che imitano l’odore dei fiori per attirare le api sono un esempio unico di mimetismo
Nel mondo degli insetti l’inganno è una strategia evolutiva sorprendentemente diffusa. Alcune orchidee imitano l’aspetto e il profumo delle femmine di certe api per farsi impollinare, mentre altri organismi sfruttano segnali chimici per confondere predatori e prede.
Un recente studio, pubblicato come preprint su bioRxiv e discusso da Nature, racconta di un caso ancora più curioso e straordinario: quello delle larve del coleottero europeo Meloe proscarabaeus, in grado di imitare l’odore dei fiori per attirare le api e sfruttarle come mezzo di trasporto verso il loro nido.
L’insetto protagonista è comunemente noto come “coleottero dell’olio”, ed è molto diffuso nei prati europei. Gli adulti di Meloe proscarabaeus sono insetti innocui, ma le larve adottano una strategia parassitaria particolarmente elaborata: appena nate, queste si arrampicano in gruppo sulle sommità dei fili d’erba e attendono il passaggio di un’ape solitaria, ma per aumentare le probabilità di riuscita del loro “apestop”, emettono una miscela di composti volatili che ricorda il bouquet aromatico dei fiori primaverili. Non appena l’ape si posa, le larve si aggrappano al corpo, e si fanno trasportare fino al nido, dove consumano le uova, il nettare e il polline, necessari per il loro sviluppo a spese dell’ospite. È un’illusione, un trucco chimico così convincente che le api si avvicinano come farebbero con una vera infiorescenza.
Nel dettaglio, il team di ricercatori del Max Planck Institute for Chemical Ecology ha mostrato che le larve producono monoterpenoidi tipici delle piante, tra cui linalool ossido e lilac aldeide, molecole che notoriamente attirano gli insetti impollinatori.

Quando i ricercatori hanno confrontato le caratteristiche chimiche delle larve con quelle dei fiori, la somiglianza è stata sorprendente: nei test comportamentali, effettuati su esemplari di Osmia bicornis e Colletes similis, le api hanno scelto sistematicamente l’odore delle larve rispetto a quello dei vegetali.
A differenza di altri casi di inganno sensoriale basati su feromoni sessuali, questa strategia attira sia maschi sia femmine (che però sono le sole a tornare al nido). Il meccanismo biochimico alla base della produzione dei composti odorosi è altrettanto affascinante, poiché le larve utilizzano enzimi simili a quelli delle piante: è
un esempio di evoluzione convergente, che spiega come organismi distanti possono sviluppare soluzioni simili relativamente a necessità analoghe.
Per la comunità scientifica lo studio apre a nuove domande: quanto è diffuso il mimetismo olfattivo nel mondo animale? E quante altre interazioni restano invisibili ai nostri sensi?
Gli autori sono del parere che questo tipo specifico di mimetismo, che si può definire “mimetismo chimico”, sia molto più comune di quanto si creda, ma estremamente difficile da individuare dal momento in cui l’olfatto umano è poco sensibile rispetto a quello degli insetti. (M. O.).

Dopo la diffusione del celebre “granchio blu” (Callinectes sapidus) la laguna di Venezia sta avendo a che fare con la comparsa di un’altra specie invasiva: quella della “noce di mare”, uno ctenoforo quasi invisibile che si sta riproducendo nel bacino dell’Alto Adriatico con impressionante rapidità. Questo invertebrato, il cui nome scientifico è Mnemiopsis leidyi, proviene dalla costa atlantica americana, ed è considerato una delle cento specie invasive più dannose al mondo.
Un recente studio dell’Università di Padova e dell’Istituto Nazionale di Oceanografia e di Geofisica Sperimentale (OGS), pubblicato su Estuarine, Coastal
and Shelf Science, racconta come Mnemiopsis leidyi sembra essersi ormai stabilita in modo permanente nel bacino adriatico. La sua presenza, inizialmente episodica, è diventata costante negli ultimi dieci anni, ed è stata favorita dall’aumento delle temperature e dalla crescente instabilità degli ecosistemi lagunari. A differenza delle meduse, con cui viene spesso confusa, Mnemiopsis leidyi appartiene al gruppo degli ctenofori, organismi privi di cellule urticanti, ma dotati di ciglia luminose che le permettono di muoversi. La sua pericolosità per l’ecosistema, dunque, non deriva da punture o tossine, bensì dal fatto che tale specie si nutre di uova di pesci, larve, cro -
La specie aliena Mnemiopsis leidyi sta mettendo a rischio l’ecosistema e la pesca nella laguna veneziana
stacei, molluschi e di plancton, i quali costituiscono la base della rete trofica adriatica. In un ambiente “chiuso”, e dunque delicato, come quello della laguna, la pressione esercitata da questa specie altera profondamente gli equilibri dell’habitat, sottraendo risorse alle specie autoctone e riducendo il reclutamento delle popolazioni ittiche. Inoltre, la “noce di mare” sta rappresentando un ulteriore fattore di crisi per i pescatori locali, già colpiti dall’espansione del granchio blu. Lo studio ha documentato una presenza elevata di Mnemiopsis in diverse aree della laguna, in particolar modo durante il periodo estivo. La straordinaria tolleranza alle variazioni di salinità e temperatura, le sta consentendo di prosperare in ambienti instabili e antropizzati, e la capacità di riprodursi tramite accoppiamento o autofecondazione non fa che accelerare la sua ascesa. Il tragico precedente che ha messo in allarme la comunità scientifica è l’invasione del Mar Nero da parte di Menmiopsis negli anni ’80, un evento che ha causato il collasso delle risorse ittiche locali. li scienziati avvertono che la gestione della “noce di mare” non deve basarsi su interventi diretti, i quali sono fattualmente impossibili per un organismo così particolare, e che l’unica strategia possibile è un monitoraggio continuo.
La presenza di Mnemiopsis leidyi nella laguna di Venezia è un fatto che racconta la vulnerabilità degli ecosistemi costieri mediterranei, alimentata dai traffici marittimi e dai cambiamenti climatici fuori controllo. L’importanza di studi come questo risiede nella comprensione delle dinamiche ecosistemiche che le specie invasive alterano, per poi, proprio attraverso tale cognizione, riuscire a proteggere o a ripristinare gli equilibri violati. (M. O.).
Sorpresa nelle acque
della Nuova Zelanda: un gruppo di ricercatori ha individuato un raro esemplare di oltre 4 metri
Una scoperta - è proprio il caso di scriverlo - enorme. A realizzarla sono stati i biologi marini della Te Herenga Waka-Victoria University di Wellington, che nelle acque di Aotearoa, in Nuova Zelanda, hanno individuato corallo nero gigante - alto quattro metri e largo 4,5 metri -, che - si stima - potrebbe avere tra i 300 e i 400 anni. Da tempo i ricercatori esplorano le profondità del Fiordland, una remota regione nel sud-ovest dell'Isola del Sud della Nuova Zelanda, con l’obiettivo di studiare e salvaguardare la biodiversità marina e in particolare dei coralli, che sono specie protetta.
Quello individuato è tra i più grandi mai avvistati. E si tratta di una scoperta decisamente importante in quanto i coralli di grandi dimensioni forniscono una riserva riproduttiva vitale per questa specie. Come spiegato dal professor Jason Bell, biologo marino presso l’ateneo di Wellington, «è di gran lunga il corallo nero più grande che abbia mai visto nei miei 25 anni di esperienza.
La maggior parte dei coralli neri che incontriamo durante le immersioni sono piccoli, mentre quelli più grandi di solito non superano i due o tre metri di altezza, quindi trovarne uno è stato davvero fantastico». Sulla stessa lunghezza Richard Kinsey, guardia forestale per la biodiversità presso il Dipartimento di Conservazione, che ha preso parte all’immersione quando è stato trovato il corallo. «Vedere un corallo così grande emergere dall'oscurità è stato davvero speciale. È senza dubbio il più grande che ricordo di aver mai visto». I ricercatori della Victoria University collaborano con il Dipartimento per la conservazione e i Fiordland Marine Guardians per studiare e mappare la distribuzione delle specie di coral -

lo protette nei fiordi. Nonostante il nome possa trarre in inganno, il corallo nero è in realtà di colore bianco, mentre solo lo scheletro è nero e rientra tra le specie protette. «Individuare con precisione dove si trovano i coralli più grandi significa poterli proteggere meglio, facendo sapere alla gente dove non ancorare le proprie barche» rimarca Bell. Il loro ruolo risulta prezioso, poiché sono in grado di creare microhabitat su cui si fissano e vivono molti organismi marini. Sono veri e propri hotspot di biodiversità, dal momento che accolgono pesci, crostacei, molluschi e invertebrati, che usano i coralli come rifugio, siti di foraggiamento o nursery
naturali. Nello stesso tempo, però, risultano estremamente vulnerabili ai cambiamenti e soprattutto alle attività umane: in questo scenario si inserisce la figura del biologo marino, che potrebbe essere definito una sentinella del mare. Sì, perché i biologi osservano, analizzano, ma soprattutto difendono gli oceani, che - lo ricordiamo - producono gran parte dell’ossigeno che respiriamo. Perennemente in prima linea così da garantire un contributo fondamentale per la tutela delle risorse marine, messe a dura prova dall’inquinamento e dal cambiamento climatico. Minacce, queste, contro cui risulta sempre più difficile combattere. (D. E.).

Ricercatori di Oxford hanno ingegnerizzato proteine con proprietà quantistiche, aprendo una nuova frontiera nella biotecnologia e nelle future applicazioni biomediche

Un team di ingegneri dell’Università di Oxford ha creato una nuova classe di biomolecole chiamate proteine fluorescenti magnetosensibili (MFP), la cui fluorescenza può essere modulata da campi magnetici e onde a radiofrequenza tramite processi quantistici attivati dall’esposizione alla luce. Il lavoro, pubblicato sulla rivista scientifica Nature, rappresenta una svolta nelle biotecnologie e un passo fondamentale per passare dall’osservazione degli effetti quantistici in natura alla loro progettazione e integrazione in molecole biologiche destinate ad applicazioni concrete.
Come spiegato nello studio, le tecnologie di rilevamento che sfruttano i fenomeni quantistici per la misurazione stanno trovando sempre più applicazioni nei campi delle scienze dei materiali, fisiche e biologiche. Fino a poco tempo fa, i candidati biologici per i sensori quantistici erano limitati ai sistemi in vitro, avevano una scarsa sensibilità ed erano soggetti a degrado indotto dalla luce. Queste limitazioni ostacolavano le applicazioni biotecnologiche pratiche e gli studi ad alta produttività che avrebbero facilitato la loro progettazione e ottimizzazione. La nuova classe di proteine fluorescenti magnetosensibili permette invece di superare molte di queste limitazioni.
Gli autori dello studio chiariscono che le MFP sono state progettate per poter interagire non solo con la luce, ma anche con campi magnetici e onde radio. Quando le MFP vengono illuminate con una lunghezza d’onda specifica, al loro interno si attivano particolari interazioni quantistiche che ne modificano il comportamento fluorescente, rendendo possibile la risposta agli stimoli magnetici. Sebbene gli effetti quantistici siano stati già dimostrati come fondamentali per alcuni processi biologici (come l’orientamento negli uccelli migratori), questa è la prima volta che sono
LE
PROTEINE
FLUORESCENTI
MAGNETOSENSIBILI (MFP) SONO
STATE PROGETTATE PER POTER INTERAGIRE NON SOLO CON LA LUCE, MA ANCHE CON CAMPI MAGNETICI E ONDE RADIO.
QUANDO LE MFP VENGONO ILLUMINATE CON UNA LUNGHEZZA
D’ONDA SPECIFICA, AL LORO INTERNO SI ATTIVANO
PARTICOLARI INTERAZIONI QUANTISTICHE CHE NE MODIFICANO IL COMPORTAMENTO FLUORESCENTE, RENDENDO POSSIBILE
LA RISPOSTA AGLI STIMOLI MAGNETICI
progettati per creare una nuova famiglia di tecnologie che offrono applicazioni pratiche.
Le proteine fluorescenti tradizionali, ampiamente utilizzate nella biologia molecolare, rispondono solo alla luce. Questo limita la loro efficacia in tessuti complessi, dove la luce può disperdersi o attenuarsi. Le nuove MFP superano questo limite collegando la fluorescenza alle interazioni con campi magnetici, permettendo nuovi modi per localizzarle e tracciarle all’interno delle cellule viventi con maggiore precisione.
Nell’ambito dello studio, il team ha già esplorato le applicazioni delle MFP nella biomedicina creando un prototipo di strumento di imaging in grado di localizzarle utilizzando un meccanismo simile alla risonanza magnetica (MRI). In particolare, lo strumento sarebbe in grado di tracciare molecole specifiche o monitorare l’espressione genica all’interno di un organismo vivente. Questo tipo di misurazioni sono fondamentali, per esempio, per la somministrazione mirata dei farmaci e per seguire nel tempo i cambiamenti genetici all’interno dei tumori.
Per generare le proteine ingegnerizzate, il team di ricerca ha utilizzato una tecnica moderna di bioingegneria nota come evoluzione diretta. In questo metodo, vengono introdotte mutazioni casuali nella sequenza
di DNA che codifica per la proteina, creando migliaia di varianti con proprietà alterate. Da questa collezione vengono selezionate le varianti più performanti e il processo viene ripetuto. Dopo molti cicli consecutivi di evoluzione diretta, le proteine selezionate hanno evidenziato un significativo aumento della loro sensibilità ai campi magnetici. Gabriel Abrahams, primo autore dell’articolo, ha dichiarato: «Ciò che mi stupisce è il potere dell’evoluzione: non sappiamo ancora come progettare da zero un sensore quantistico biologico davvero efficace, ma guidando con attenzione il processo evolutivo nei batteri, la natura ha trovato una soluzione al nostro posto».
Gli scienziati sottolineano che il raggiungimento dei risultati che hanno permesso di sviluppare la nuova tecnologia ha richiesto un approccio interdisciplinare ambizioso, che ha unito per la prima volta le competenze in ingegneria biologica, quantistica e intelligenza artificiale, tre aree di innovazione in grande sviluppo.
Harrison Steel, autore responsabile dello studio, ha dichiarato: «Il nostro studio ha messo in luce quanto sia difficile prevedere il tortuoso percorso che porta dalla scienza di base a una reale svolta tecnologica. Ad esempio, la nostra comprensione dei processi quantistici che avvengono all’interno delle MFP è stata possibile solo grazie agli esperti che hanno trascorso decenni a studiare come gli uccelli si orientano utilizzando il campo magnetico terrestre. E le proteine che hanno fornito il punto di partenza per la progettazione dei MFP provenivano dall’avena comune!».
Dopo il successo del progetto, il team sta ora accelerando il lavoro per realizzare numerose applicazioni della scoperta e approfondire la comprensione degli effetti quantistici in natura, nell’ambito di un importante progetto recentemente avviato dalla stessa Università di Oxford. (S. B.).